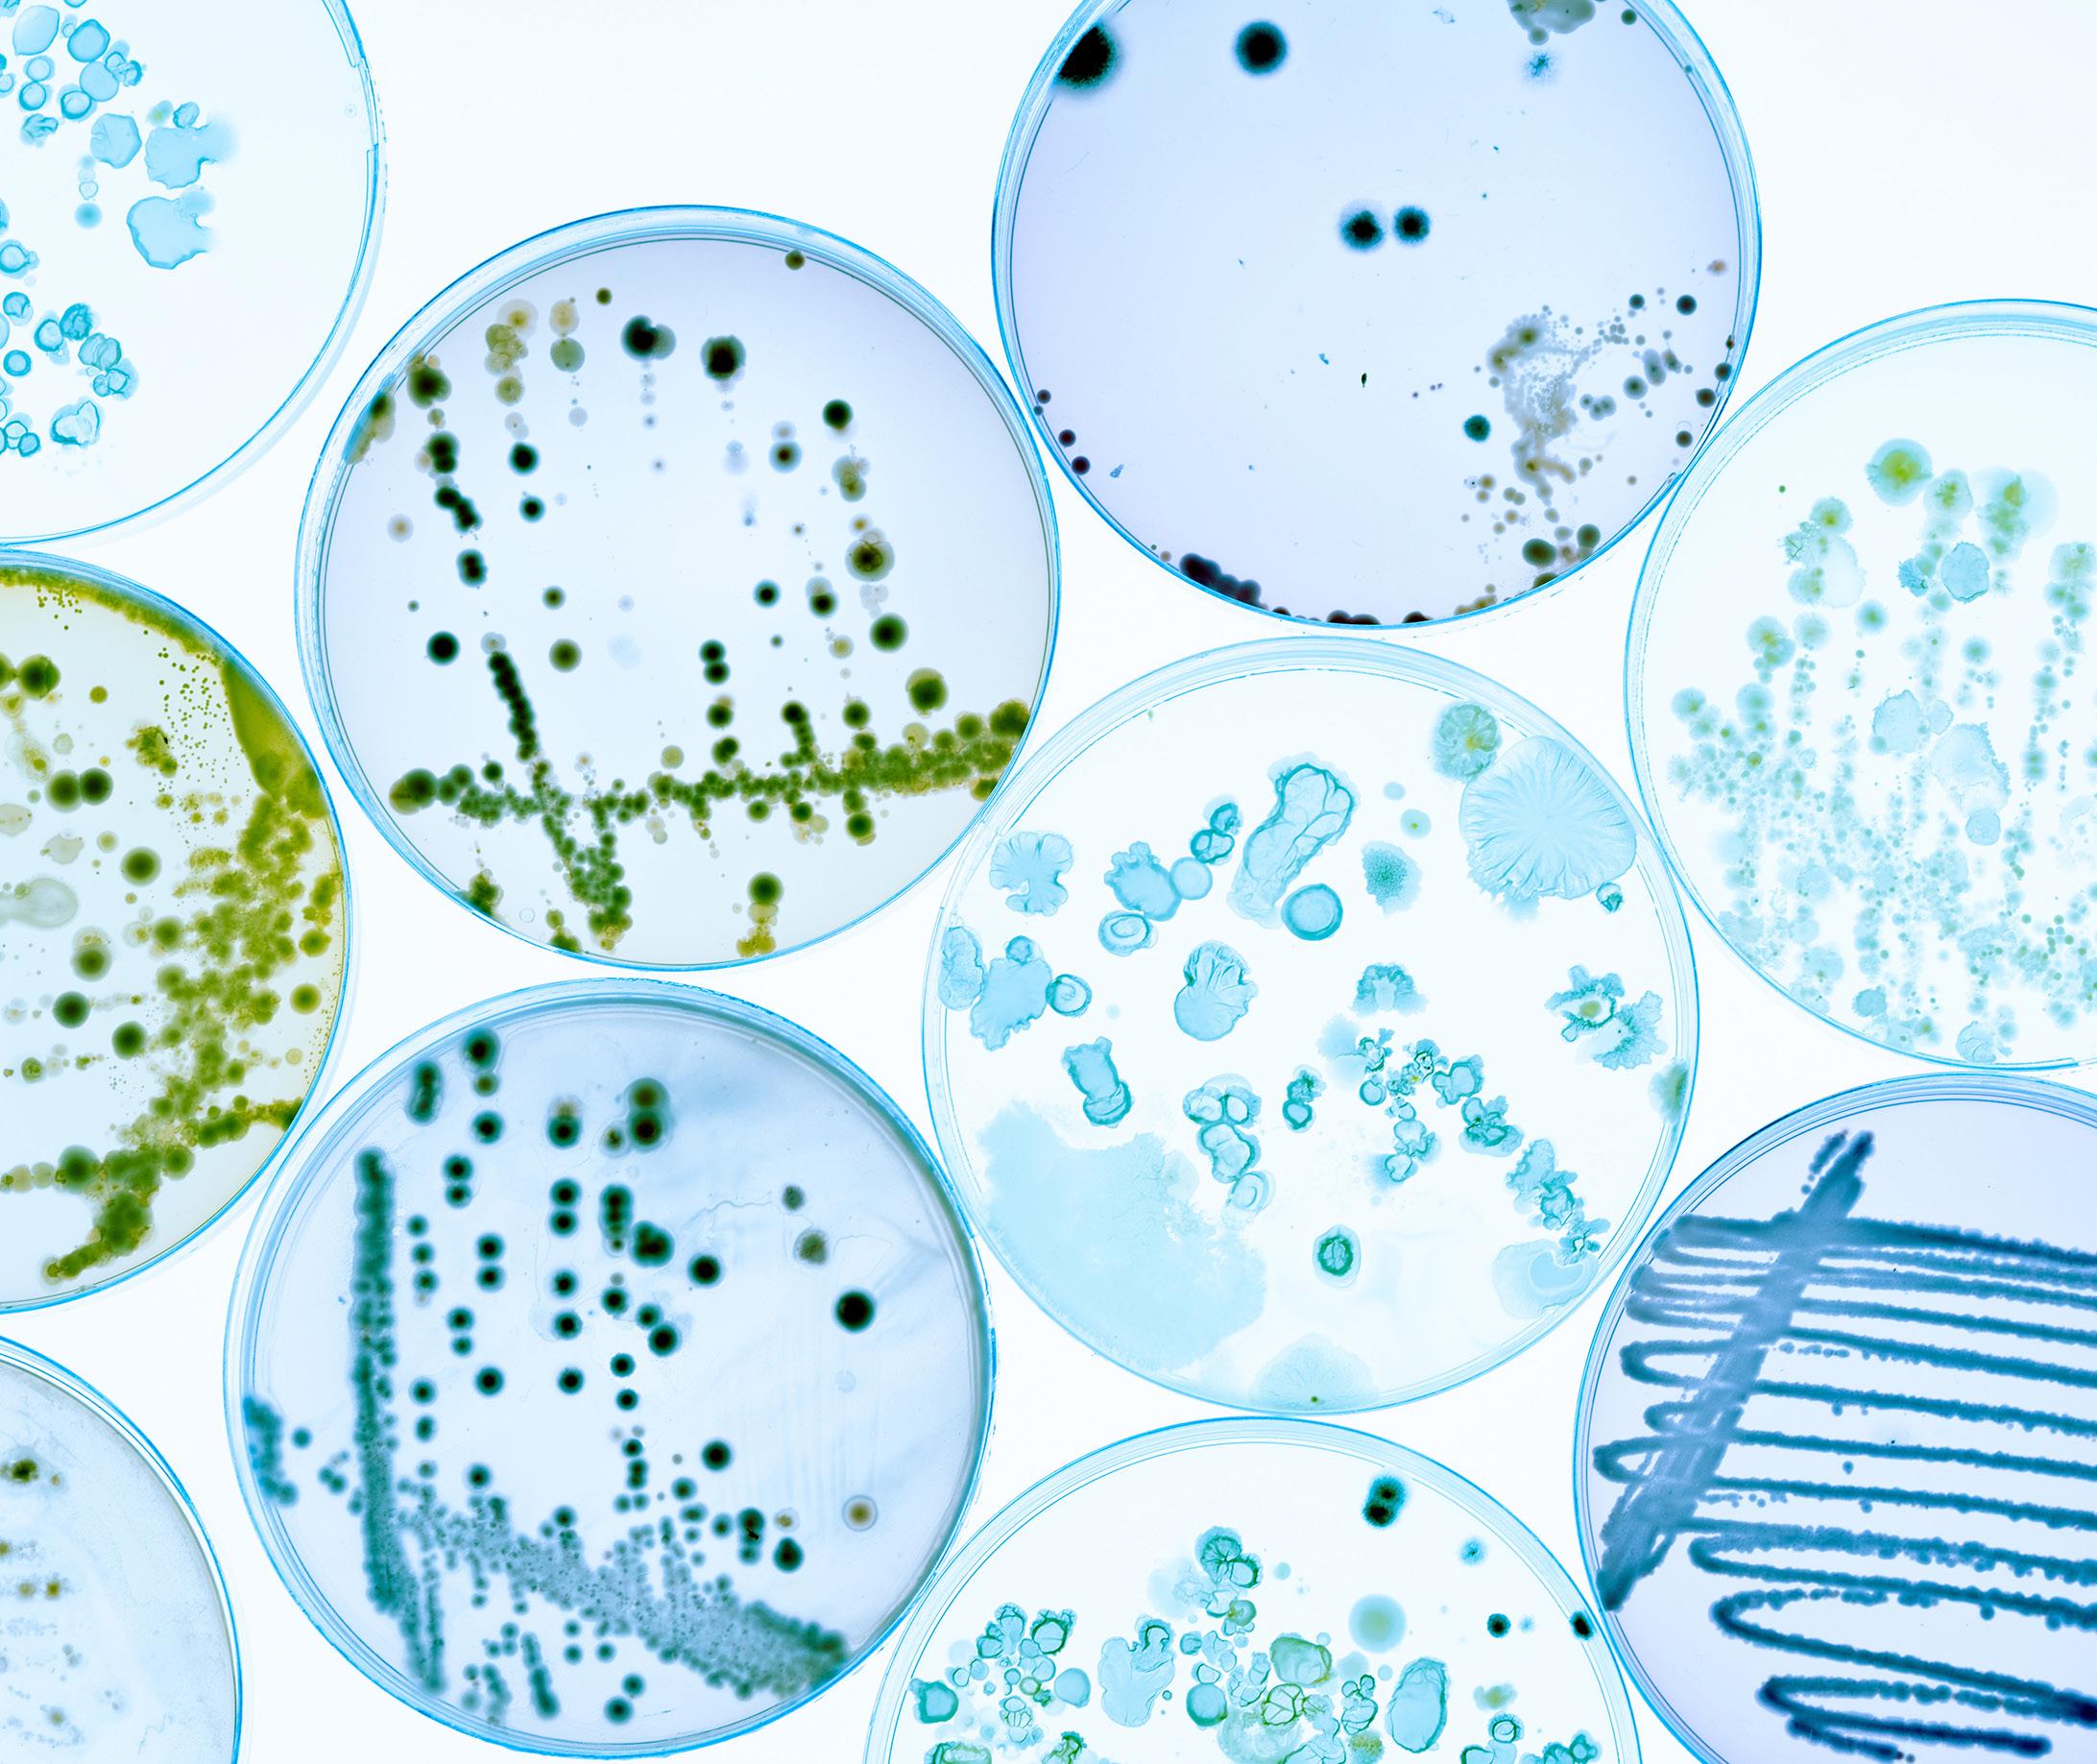

3|2023
kaikki genetiikalla työskentelevät!
Bioanalyytikkoliiton genetiikan ryhmä etsii koko Suomen yliopistosairaaloiden genetiikan laboratorioissa työskenteleviä bioanalyytikoita ja laboratoriohoitajia mukaan verkostoitumaan.
Aloitamme alkusyksystä yhteisellä iltapäiväkahvihetkellä Teamsin välityksellä ja suunnittelemme tulevaa yhteistä toimintaa osallistujien kiinnostuksen mukaan.
Vapaamuotoiset ilmoittautumiset kutsulinkin lähettämistä varten osoitteeseen toimisto@bioanalyytikot.fi.
Innostunein terveisin, Bioanalyytikkoliiton genetiikan ryhmä
Suomen Bioanalyytikkoliitto ry Finlands Bioanalytikerförbund rf
www.bioanalyytikkoliitto.fi
Yhteystiedot
PL 110, 00060 TEHY
toimisto@bioanalyytikot.fi
p. 050 302 6504
järjestösihteeri: Kaija Sopenlehto
Puheenjohtaja
Jenni Kalliomäki jenni.kalliomaki@bioanalyytikot.fi
p. 044 237 0028
Päätoimittaja, ilmoitusmyynti ja taitto
Jenni Niiranen jenni.niiranen@bioanalyytikot.fi
p. 050 324 7646
Toimituskunta
Jenni Kalliomäki
Mika Paldanius
Kaija Sopenlehto
Niina Wahlroos
Kirsi Kiipeli
Marja Kaski-Honkanen
Jenni Hänninen
Kati Koivisto
Sina Nordman
Ilmoitushinnat
www.bioanalyytikkoliitto.fi

Lehden ilmestyminen 2023 e-lehtenä (aineistopäivä sulkeissa)
Nro 4 ilmestyy 8.12. (22.11.)
Kannen kuva AdobeStock
Terveisin Jenni K.

Syksy tekee tuloaan ja kesä alkaa olla takanapäin. Tänä kesänä lomailin jo kesäkuussa ja loma tuli todellakin tarpeeseen. Koronavuodet ovat takanapäin ja koronakiireen piti jäädä taakse, vaan toisin kävi. Henkilöstöpula näkyy lähes kaikissa laboratorioissa eikä tunnu helpottavan ihan heti. Meillä tuntuu olevan luontainen tarve auttaa kaveria hädässä ja uuvuttaa itsemme valtaisan työtaakan alle. Jotta meillä tulevaisuudessakin olisi hyvinvoivia ja ammattitaitoisia bioanalyytikoita työelämässä, tulisi meidän muistaa pitää huolta omasta hyvinvoinnistamme.
Fyysisestä hyvinvoinnista on hyvä huolehtia oikeanlaisen ravinnon, liikunnan ja riittävän unen myötä. Ei se aina helppoa ole, etenkään riittävän unen saaminen kolmivuorotyöntekijänä. Henkistä hyvinvointia ei myöskään tulisi unohtaa ja on hyvä tehdä säännöllisesti asioita, jotka tuottavat itselleen hyvää oloa.
Ajanhallinta on elintärkeää. Laadi itsellesi päivittäinen aikataulu, mikäli se auttaa suoriutumaan arjen tehtävistä. Näin pystyt välttämään kiirettä ja stressiä. Priorisoi tehtäviä ja suostu vain sellaisiin tehtäviin, joihin tiedät oman aikasi ja jaksamisesi riittävän. Aseta omat rajasi ja opi sanomaan ei asioille, jotka kuormittavat sinua liikaa. Tämä auttaa välttämään stressiä.
Hyvinvoiva bioanalyytikko jaksaa myös kouluttautua ja tuohan ulkopuolinen koulutus pienen hengähdyshetken työpaikan mahdollisesta kiireestä. Laboratoriolääketiede ja näyttely -tapahtuma juhlii tänä vuonna 30-vuotista taivaltaan. Tervetuloa kuuntelemaan mielenkiintoisia luentoja ja verkostoitumaan kollegoiden kanssa Helsinkiin lokakuussa.
Valtakunnallista Bioanalyytikoiden Opintopäivää vietetään marraskuussa Seinäjoella. Toivottavasti tapaamme myös siellä. Lakeuden Bioanalyytikot ovat suunnitelleet meille erinomaisen luentopäivän.
Oikein ihanaa syksyä kaikille!
Hösten är på väg och sommaren är nu bakom oss. Den här sommaren tog jag redan ledigt i juni, och semestern var verkligen vid behov. Coronaåren är över, och coronastressen borde ha lämnats bakom, men det blev inte riktigt så. Personalbristen syns nästan överallt på laboratorierna och verkar inte lätta upp snart. Det verkar som om vi har en naturlig benägenhet att hjälpa våra kollegor i nöd och utmattar oss själva under en enorm arbetsbörda. För att vi även i framtiden ska ha välmående och kompetenta bioanalytiker i arbetslivet bör vi komma ihåg att ta hand om vår egen välmående.
Det är viktigt att se till sin fysiska hälsa genom rätt kost, motion och tillräcklig sömn. Det är inte alltid enkelt, särskilt att få tillräckligt med sömn som skiftesarbetare. Vi får inte heller glömma bort vår mentala hälsa och det är bra att regelbundet göra saker som ger oss en god känsla.
Tidsstyrning är avgörande. Skapa en daglig tidtabell om det hjälper dig att hantera vardagens uppgifter. På så sätt kan du undvika stress och kaos. Prioritera uppgifter och acceptera bara de som du vet att du har tid och energi för. Sätt dina egna gränser och lär dig säga nej till saker som överbelastar dig. Detta hjälper dig att undvika stress.
En välmående bioanalytiker har också energi att fortsätta sin utbildning, och extern utbildning kan ge en kort paus från arbetsplatsens eventuella stress. Laboratoriolääketiede ja näyttely -evenemanget firar i år sitt 30-årsjubileum. Välkommen att lyssna på intressanta föreläsningar och nätverka med kollegor i Helsingfors i oktober.
Den nationella Bioanalytikernas studiedag firas i november i Seinäjoki. Förhoppningsvis ses vi även där. Lakeuden Bioanalytiker har planerat en utmärkt föreläsningsdag för oss.
Önskar er alla en härlig höst!
Bioanalyytikko 3|2023 3
Pääkirjoitus Jenni
Bioanalyytikkoliiton puheenjohtaja
Katri Särkikoskesta vuoden unihoitaja Jenni Kalliomäki 08 Koulutuksen ja työelämän yhteistyöpäivä Hänninen & Nordman
Kongressipäiväkirja: Neurofysiologiaa Marseillessa Linnavuori & Kärpijoki
13 Hoitoon liittyvien infektioiden opetus haltuun Aasiassa Korhonen et al.
16 Pariohjaus opiskelijoiden ohjausmenetelmänä kliinisessä laboratoriossa Liehu
24
Motivaatio, hyvinvointi ja kokemus työn merkityksellisyydestä tuo sote-alalle osaavia ja työtään arvostavia ammattilaisia myös tulevaisuudessa Moberg & Lahti
28
Turvassa töissä Niina Wahlroos
30
Bioanalyytikkoopiskelijoiden näkemys alan veto- ja pitovoimatekijöistä Kokkonen & Virtanen
36
Nenäsumutteesta ase tuleviin pandemioihin? Leskelä et al.
38
Lyhyet Ajankohtaista asiaa
03
Kalliomäki
06
10
#VBO2023 Valtakunnallinen
Bioanalyytikoiden Opintopäivä

lauantaina 18.11.2023
Frami, Seinäjoki
Ohjelma
8.30 Ilmoittautuminen, kahvi ja näyttelyyn tutustuminen
9.00 Opintopäivän avaus – Maija-Kaisa Laitinen, puheenjohtaja, Lakeuden Bioanalyytikot ry
9.05 Näytteilleasettajat esittäytyvät
9.15 Geenitutkimusten nykytilanne
10.00 Syövän molekyylipatologia keskussairaalatasolla
Satu Luhtala, sairaalasolubiologi, Etelä-Pohjanmaan hyvinvointialue
10.45 Lounas ja näyttelyyn tutustuminen
12.00 Juhlapuhe - Katse tulevaisuuteen
Petra Anttila, kehitysjohtaja, Sairaalakemisti FT, Etelä-Pohjanmaan hyvinvointialue
12.30 Huumausaineiden käytön nykytilanne Etelä-Pohjanmaalla ja koko Suomessa
Matti Tiainen, komisario, Etelä-Pohjanmaan poliisi
13.15 Haasteet huumausaineanalytiikassa – Löytyvätkö muuntohuumeet tämän hetken menetelmillä?
Petri Kylli, kemisti, Synlab Oy
14.00 Kahvi ja näyttelyyn tutustuminen
14.30 Sisäinen joustavuus hektisessä työympäristössä
Ville Köykkä, mielenterveyshoitaja, fysioterapeutti, Etelä-Pohjaanmaan hyvinvointialue
15.15 Iltapäivän kevennys
15.45 Opintopäivän päätös
Osallistumishinnat:
Varsinaiset jäsenet 90 € | Opiskelija- tai eläkejäsenet 25 €
Ilmoittautuminen päättyy 5.11.23.

Ilmoittaudu nyt: www.lyyti.in/VBO2023
KATRI SÄRKIKOSKESTA VUODEN UNIHOITAJA
Suomen Unihoitajaseura valitsee vuosittain Vuoden
Unihoitajan. Valittavan tulee olla Unihoitajaseuran jäsen, joka on tuonut esiin hyvän unen merkitystä, kehittänyt omaa osaamistaan tai ollut aktiivisesti mukana
Unihoitajaseuran toiminnassa. Tamperelainen Katri Särkikoski on 16. SUHS ry:n vuoden Unihoitaja, jonka valintaperusteena Vuoden Unihoitajaksi on monipuolinen työ unen tutkimuksen ja hoidon parissa. Lisäksi hän on kehittänyt ja vahvistanut ammatillista osaamistaan jakaen sitä unihoitajien parissa.
Katri Särkikoski on tamperelainen bioanalyytikko (yamk), unihoitaja ja uniteknikko. Hän on valmistunut bioanalyytikoksi Tampereen ammattikorkeakoulusta 2012 ja suorittanut ylemmän ammattikorkeakoulututkinnon keväällä 2023 Oulun ammattikorkeakoulussa, suuntautumisvaihtoehtona hyvinvointia edistävien digipalveluiden asiantuntija.
Valmistumisen jälkeen Katri työskenteli lyhyen pätkän patologian laboratoriossa kudosnäytteiden valussa. Hän sai pian paikan silloisen PSHP:n Kuvantamiskeskuksen ja apteekkiliikelaitoksen kliinisen neurofysiologian labrasta, jossa pääsääntöisesti työskenteli video-EEG:ssa 3-vuorotyössä. Video EEG:n lisäksi hän teki elektiivisiä ja päivystyksellisiä EEG-tutkimuksia laboratoriossa ja TAYS:n vuodeosastoilla. Muutamaa vuotta myöhemmin Katri pääsi perehtymään kliini-
sen neurofysiologian laboratorion yhteydessä olleeseen unilaboratorioon. Unilaboratoriossa tehdään uni- ja vireystilatutkimuksia sekä CPAP-hoidon aloituksia.
Vuonna 2018 Katri aloitti keikkatyöt silloisessa Oivaunessa, nykyisin Coronaria Uniklinikka, jonne hän siirtyi vakituiseksi työntekijäksi maaliskuussa 2019. Siellä työskennellessään hän suoritti European Sleep Research Society:n Somnologist Technologist -pätevyyden, jonka myötä hän sai Suomen Unihoitaja- ja Unitutkimusseurojen myöntämän unihoitajapätevyyden.
Katri oli iloinen ja yllättynyt tullessaan valituksi vuoden unihoitajaksi. Potilaat kysyvät usein hänen koulutuksestansa ja Katri kertoo olevansa bioanalyytikko. Katri kertoo, että kaikki hänen työpaikkansa ovat olleet moniammatillisia. Kollegoissa on ollut sairaanhoitajia, kätilöitä ja lähihoitajia lääkärien lisäksi. Valintaperusteissa Suomen Unihoitajaseura mainitsi monipuolisen koulutuksen ja halun kehittää itseään sekä ammattitiedon ja -taidon jakamisen kollegoille. Ilokseen Katri onkin päässyt kertomaan urapolustaan myös bioanalyytikko-opiskelijoille.
6 Bioanalyytikko 3|2023
TEKSTI Jenni Kalliomäki KUVA Janne Kanervisto


Bioanalyytikko 3|2023 7
Koulutuksen ja työelämän yhteistyöpäivästä vetoa ja pitoa bioanalyytikon työhön
Bioanalyytikkoliiton syksyn koulutusrupeama käynnistyi 1.9 Pasilassa Koulutuksen ja työelämän yhteistyöpäivällä. Koulutus nostaa esiin asioita sekä keskustelua koulutuksen ja työelämän kehittämiseksi. Lisäksi päivä luo koulutuksen ja työelämän edustajille mahdollisuuden verkostoitua ja oppia uutta työnsä tueksi.
Mitä kuuluu bioanalytiikan koulutukselle?
Tänä vuonna vietetään bioanalytiikkakoulutuksen 70vuotisjuhlavuotta. Avausluennolla Savonia-AMK:n lehtori Sanna Kolehmainen kertoi kuulumiset koulutuksesta.
Bioanalytiikan vetovoima on säilynyt kohtalaisen hyvänä. Viime vuosina työhön sitoutuminen on heikentynyt. Uraseurantakyselyn mukaan viisi vuotta valmistumisen jälkeen yhä useampi bioanalyytikko tekee muuta kuin bioanalyytikon työtä. Olisikin tärkeää keksiä yhdessä keinoja alan pitovoiman lisäämiseksi.
Koulutuksessa pyritään huomioimaan oppimisen tuen tarpeet ja opiskelijoille järjestetään yksilöllisiä erityisjärjestelyjä. Opinnoissa pyritään vastaamaan työelämän muuttuviin osaamistarpeisiin esimerkiksi työelämälähtöisten opinnäytetöiden ja hankkeiden muodossa. Satelliittikoulutuksilla vastataan alueelliseen työvoiman tarpeeseen. Niistä innostuvat usein henkilöt, joilla ei ole mahdollista opiskella toiselle paikkakunnalla.
Kohtaavatko työpaikan ja työntekijöiden toiveet ja tarpeet?
Sinalab Oy:n toimitusjohtaja Sina Nordman esitteli keinoja, joilla edistää työntekijöiden sitoutuneisuutta. Samalla hän kertoi, mitä bioanalyytikot toivovat työuraltaan. Moni toimiala kärsii työvoimapulasta ja myös laboratorioissa henkilöstöpula on vakava.
Vastavalmistuneilla bioanalyytikoilla on suuri halu ja potentiaali kehittää osaamistaan. Moni bioanalyytikko jo pian valmistumisen jälkeen siirtyy opiskelemaan jatkotutkintoa tai uutta alaa. Varsinkin nuorempi sukupolvi kaipaa monipuolisuutta, urakehitystä sekä vaikutusmahdollisuuksia. Enää ei etsitä koko työuran pituista työsuhdetta, vaihtelu ja kehittyminen innostaa. Työn, vapaa-ajan ja perheen yhteensovittaminen korostuu. Ikävät kokemukset työelämässä voivat lisätä alanvaihtoajatuksia. Siksi on tärkeää, että meistä jokainen muistaa työssään toimia kollegiaalisesti.
8 Bioanalyytikko 3|2023
TEKSTI Jenni Hänninen & Sina Nordman
Koulutuspaikkojen lisääminen ei yksin riitä turvaamaan riittävää henkilöstömäärää. Ihmisten erilaiset tarpeet huomioivalla koko tiimin motivaatiojohtamisella voidaan kannustaa työhön, joka on palkitsevaa ja siihen sitoudutaan. On tärkeää kiinnittää huomiota siihen, miten sanoitamme omaa työtämme. Potilasturvallisuuden ja laadun kannalta on oleellista, että laboratorioiden henkilöstön koulutustaso ei laske. Voimakkaassa kasvussa oleva laboratorioala tarvitsee tulevaisuudessa osaavaa henkilökuntaa, joilla on syvää substanssiosaamista ja vaativan teknologian käyttötaitoja.
Alan pitovoiman vahvistaminen
Koulutuspäivän paneelikeskustelun aiheena oli ”Miten koulutus ja työelämä voisivat vahvistaa alan pitovoimaa?”. Panelisteina olivat työnantajan edustajana ISLABista ylihoitaja Merja Ålander, työntekijöiden edustajana Fimlabista bioanalyytikko Oona Ahtinen, koulutuksen edustajana Turun AMK:sta koulutuspäällikkö Heidi Kalve sekä opiskelijaedustaja Laura Karjalainen Turun AMK:sta. Teemoina keskustelussa olivat työntekijän arvostaminen ja huomioiminen sekä opiskelijoiden kohtaaminen työelämässä.
Kohtaako koulutus työelämän tarpeet?
Opintojen aikana opitaan teoria, mutta suurin osa käytännön työstä opitaan työelämässä. Opiskelijalla voi olla hyvät teoreettiset taidot, mutta vastaako mielikuva työstä todellisuutta? Opettajilla ei ole mahdollisuutta antaa kokonaisvaltaista kuvaa työstä. Opintoihin hakeutuessa opiskelijalla on voinut olla virheellinen kuva bioanalyytikon työstä.
Opiskelijaohjaajan rooli on tärkeä sen kannalta, millaisen kuvan opiskelija saa alasta. Opiskelijaa tulisi rohkaista etsimään ja löytämään omat vahvuudet. Opiskeluaikana voi pohtia toiveita tulevasta työstään.
Opiskelijoiden ohjaaminen on myös rekrytointiväylä. Millaisen mielikuvan annat omasta työpaikastasi? Haluaako opiskelija palata takaisin harjoittelujakson jälkeen? Opiskelijan kohtaaminen on tärkeää. Kiireen keskellä annettu hymy ja tervehdys luovat positiivista kuvaa.
Mitkä ovat asioita, jotka kasvattavat työpaikan pitovoimaa?
Työntekijät arvostavat monipuolista työtä, jossa voi kehittää alaa ja uraa. Tällä hetkellä on työtekijöiden
markkinat ja työntekijää on kuunneltava. Työntekijät arvostavat työpaikkaa, jossa tuetaan kehittymistä. Etenemismahdollisuuksien puute lisää vaihtuvuutta ja alan vaihtoa.
Työntekijä haluaa kuulua työyhteisöön. Yhteenkuuluvuutta lisää osallistaminen esimerkiksi kehitysprojekteihin mukaan ottamalla. On tärkeää muistaa myös vastavuoroisuus. Jos työnantaja suostuu joustamaan, myös työntekijä suostuu joustamaan. Vuorovaikutus on oleellista esimies-alaissuhteessa.
Säästötoimenpiteiden myötä monissa laboratorioissa analytiikkaa on keskitetty. Tämä pienentää toimintakenttää ja analyysiosaamista. Työtehtävät voivat jakautua epätasaisesti. Olisi tärkeää, että palkkaus vastaisi työn vaativuutta ja tehtävänkuvan moninaisuutta.
Miten motivoitua perehdyttämään kiireen keskellä?
Mehiläisen kehityskoordinaattori Mirkka Lahtinen esitteli keinot laadukkaaseen perehdytykseen ja kuinka motivoitua perehdyttämään kiireessä. Perehdytys on käyntikortti, sana hyvästä tai huonosta perehdytyksestä leviää nopeasti. Perehdytyksen avulla uusi työntekijä sopeutuu työyhteisöön.
Hyvä perehdyttäjä on kiinnostunut, huolehtii osaamisestaan sekä antaa ja ottaa vastaan palautetta. Kaikilla työntekijöillä on velvollisuus perehdyttää uusia työntekijöitä. Perehdyttäminen on tiimityötä, josta koko työyhteisö on vastuussa.
Suunnitelma auttaa perehdytyksen etenemisessä ja ohjaa kulkua. Perehdytykselle pitää olla laadittuna selkeät tavoitteet. Kiireen keskellä se auttaa motivoitumaan perehdyttämiseen. Suunnitelman pohjalta tiedetään etukäteen ketä, minä päivinä ja mitä perehdytetään. Turha perehdyttämisestä aiheutuva stressi häviää.
Koulutuspäivä oli onnistunut ja lämminhenkinen. Kiitos koulutuspäivään osallistuneille, esiintyjille sekä koulutuspäivän järjestäneille työryhmän jäsenille.
Jenni Hänninen, laitehallintakoordinaattori, bioanalyytikko (YAMK), Fimlab Laboratoriot Oy
Sina Nordman, toimitusjohtaja, Sinalab Oy
Bioanalyytikko 3|2023 9
NEUROFYSIOLOGIAA MARSEILLESSA
TEKSTI ja KUVAT Elina Linnavuori & Eeva-Liisa Kärpijoki

European Congress of Clinical Neurophysiology (ECCN)
Ranskan Marseillessa järjestettiin 9.-12.5.2023 European Congress of Clinical Neurophysiology (ECCN). Kongressin järjestivät alan kansainväliset asiantuntijat yhdessä Ranskan kliinisen neurofysiologian yhdistyksen kanssa. Joka toinen vuosi järjestettävä kliinisen neurofysiologian kongressi tarjoaa kliinisen neurofysiologian erikoisalasta kiinnostuneille mahdollisuuden kuulla uusinta tutkittua tietoa sekä tavata muita alalla työskenteleviä ja vaihtaa ajatuksia heidän kanssaan.

Matkustimme kongressiin yhdessä neljän muun Tyksin kliinisen neurofysiologian (KNF) yksikössä työskentelevän bioanalyytikon kanssa. Lähdimme matkalle ajatuksena päästä kehittämään ammatillista osaamistamme sekä kuulemaan alan uusimpia tutkimuksia innostavassa kansainvälisessä ilmapiirissä. Päivät olivat pitkiä, mutta täynnä uutta tietoa, ahaa-elämyksiä, kohtaamisia – ja hieman turistina palloiluakin.
Pääteemana kongressissa oli ”Linking bedside to theory”, minkä tarkoituksena oli luoda siltaa teoreettisen tiedon ja käytännön välille, jatkuvasti kehittyvällä alalla. Kongressissa oli yhteensä 800 osallistujaa 58 eri maasta. Suomesta osallistujia oli noin 70. Vaikka suurin osa kongressiin osallistuneista oli lääkäritaustaisia, oli osallistujien joukossa lähes 30 alalla työskentelevää hoitajataustaista ammattihenkilöä, kuten bioanalyytikkoja ja teknikkoja.
Nykyaikaisen kongressin tapaan, osallistujien oli mahdollisuus ladata ECCN-sovellus, josta näki sujuvimmin päivän ohjelman ja aikataulun sekä sai halutessaan merkittyä kiinnostavat luennot. Sovelluksen avulla organisaatio keräsi muun muassa arvioita luennoista sekä kongressin lopulla laajemmankin kokonaispalautteen. Sovelluksen kautta sai myös anottua osallistumistodistuksen.
Kongressin antia
Kongressi oli monialainen ja myös luennoitsijoita oli useista ammattiryhmistä. Aiheet käsittelivät kliinisen neurofysiologian hyödyntämistä esimerkiksi lihastautien, liikehäiriöiden ja epilepsioiden diagnostiikassa sekä vastasyntyneiden aivovaurioiden tutkimisessa.
Aiheita käsiteltiin laajasti ja esiteltiin uusimpia tutkimustuloksia ja -sovelluksia. Luennoilla syvennyttiin myös teho-osastomonitorointeihin sekä elektroenkefalografiaan yhdistetyn transkraniaalisen magneettistimulaation (TMS-EEG) ja aivojen magneettikenttämittauksen (magnetoenkefalografia, MEG) käyttöön kliinisessä diagnostiikassa tulevaisuudessa. Lisäksi kuulimme mielenkiintoisia luentoja KNF-menetelmien tärkeydestä pitkittyneen tehohoidon aiheuttamien hermo- ja lihassairauksien diagnosoinnissa.
Erilaista näkökulmaa perinteiseen neurofysiologiaan toivat luennot mm. transsista ja hypnoosista sekä erilaisten toiminnallisten neurologisten häiriöiden diag-
Bioanalyytikko 3|2023 11
Näkymä yhdestä lukuisista luentosaleista. Vasemman sivun kuvassa näkymä Notre-Dame de la Gardelta Palais du Pharolle.
nosoinnin vaikeudesta. Osa luennoista oli lisämaksullisia, mutta osallistumismaksuunkin sisältyvistä luennoista sai koottua melkoisen kongressipaketin. Kongressi sisälsi luentojen lisäksi käytännön työpajoja aamuvirkuille. Näiden lisäksi kongressissa oli nähtävillä yhteensä 320 posteria, ja ne olivat esillä joka päivä vaihtuvina posterikokonaisuuksina tekijöineen. Postereiden abstraktit olivat luettavissa kongressin omassa sovelluksessa.
Näytteilleasettajat ovat tärkeä osa kongressia ja verkostoituminen myös heidän kanssaan on aiempien vuosien kokemusten perusteella havaittu tärkeäksi. Ihan kaikkien sadan näytteilleasettajan kanssa emme ehtineet jutella, mutta pääsimme kuitenkin keskustelemaan laitteista ja tarvikkeista eri laitevalmistajien kanssa. Pääsimme myös kertomaan Suomen kierrätyskulttuurista ja tarkemmin sairaalan jätteiden kierrätyksestä Tyksissä. Oli positiivista huomata, että vastuullisuus ja ympäristöystävällisyys koetaan tärkeänä myös tällä hieman suppeammalla teollisuuden alalla sekä pohditaan, miten esimerkiksi pakkausmateriaalit saataisiin helpoimmin kierrätettyä.
Mieleen jäi erityisesti se, että tällä kertaa kongressissa oli ensimmäistä kertaa järjestetty oma sessio myös ”teknikoille”. Tälle tuntui olevan kysyntää, sillä luentoja saapui kuuntelemaan huoneen täydeltä kliinisen neurofysiologian alasta kiinnostuneita hoitajia. Luennoilla tuotiinkin esiin, että sessiolle toivotaan jatkoa ja katseet suunnattiin toiveikkaina tulevaan. Ensi kerralla meitä on toivottavasti taas paljon enemmän paikalla.
Tulevaisuudessa olisikin hienoa saada tämän kaltaisiin kongresseihin myös hoitajille ja teknikoille suunnattuja luentoja ja käytännön työpajoja.
Kongressipaikka sijaitsi Palais du Pharon alla olevassa laajennusosassa, jota ympäröi kaunis puistoalue. Sieltä oli upeat näköalat Marseillen vanhaan satamaan Vieux Portiin, jossa oli ankkuroituna lukuisia toinen toistaan hienompia purjeveneitä. Majapaikkamme oli jonkin matkaa Marseillen keskusta-alueen ulkopuolella, joten bussimatkoilla sai nauttia vaihtuvista maisemista aamuin illoin. Iltaisin, päivän luentojen jälkeen, jäi hieman aikaa kuljeskella Marseillen katuja ja käydä ihastelemassa nähtävyyksiä. Kiipesimme myös katsomaan korkealla kukkulalla, 150 metrin korkeudessa sijaitsevaa pyhiinvaelluskirkkoa Notre-Dame de la Gardea.
Kongressiin osallistumisen tärkeys Kongressiin pääseminen oli tärkeää, koska kliinisen neurofysiologian alalla ei tällä hetkellä ole kansainvälistä KNF-hoitajien järjestöä. OSET (International Organisation of Societies for Electrophysiological Technology), johon Bioanalyytikkoliittokin kuului, lopetti toimintansa vuonna 2022. Kliininen neurofysiologia on bioanalyytikoiden erikoisalana pieni, mutta jatkuvasti kehittyvä. Meidän tulee näkyä myös näissä perinteisesti ehkä enemmän lääkäreille suunnatuissa kongresseissa, jotta saamme niihin jatkossakin omia sessioita ja sitä kautta mahdollisuuksia kehittyä ammatillisesti sekä verkostoitua.
Meille tarjoutui upea tilaisuus osallistua kongressiin kannustavan työnantajan sekä Bioanalyytikkoliiton myöntämän ammatinkehittämisapurahan tukemana. Työnantajan tuen on todettu olevan tärkeässä osassa henkilöstön koulutuksiin osallistumisessa. Tämänkaltaisiin koulutuksiin osallistuminen kehittää ammatillista osaamista, joka lisää tutkitusti työn merkityksellisyyttä ja työhön sitoutumista. Kaiken kaikkiaan mielestämme kongressiin osallistuminen oli kokemuksena erittäin mielenkiintoinen ja antoisa. Haluamme rohkaista kaikkia tilaisuuden tullen hakeutumaan aktiivisesti oman alansa kansainvälisiin kongresseihin!
Elina Linnavuori, väitöskirjatutkija, TtM, bioanalyytikko, kliinisen hoitotyön asiantuntija, Tyks Kuvantaminen, Kliinisen neurofysiologian yksikkö Eeva-Liisa Kärpijoki, bioanalyytikko yAMK, tiiminvetäjä IOM, Tyks Kuvantaminen, Kliinisen neurofysiologian yksikkö
12 Bioanalyytikko 3|2023
HOITOON LIITTYVIEN INFEKTIOIDEN OPETUS HALTUUN AASIASSA
Hoitoon liittyvät infektiot (HLI) ovat terveydenhuollon globaali haaste. Ne aiheuttavat turhaa kärsimystä potilaille, pidentävät sairaalassa
oloaikoja ja tuottavat ylimääräisiä kustannuksia. Maailmanlaajuisesti 10 % potilaista saa infektion olleessaan hoidossa terveydenhuollossa.

Esimerkiksi tehohoidon potilaista 30 % saa vähintään yhden infektion hoitonsa aikana kehittyneissä maissa. Sen sijaan kehittyvissä maissa nämä infektiot ovat 2–3 kertaiset.

Bioanalyytikko 3|2023 13
TEKSTI ja KUVAT Ulla Korhonen, Leena Koponen, Mikko Myllymäki ja Marja Silén-Lipponen
Ulla standardoituna potilaana simulaatiossa Coimbrassa.
Suurin osa infektioista on kuitenkin estettävissä oikeilla käytänteillä. Tutkimuksissa on todettu, että tiedon lisääminen ja toimintatapojen kehittäminen ovat parhaita tapoja ehkäistä HLI. Aasian maissa infektioiden torjunnan opetus on ollut tehotonta ja siksi hoitohenkilökunnan tiedot ja taidot ovat jääneet puutteellisiksi. Tämän vuoksi on havaittu tarve kehittää infektioiden torjunnan koulutusta. Savonia-ammattikorkeakoulu on mukana kehitystyössä PrevInf-hankkeessa.
PrevInf-hanke infektioiden torjunnan opetuksen tukena
PrevInf (Capacitating Asia’s Nursing Students on Innovative and Sustainable Prevention and Control of Healthcare-Associated Infections) on Erasmus+ Capacity


Building -hanke, jota johtaa Nursing School of Coimbra (ESEnfC) Portugalista yhdessä Savonia-ammattikorkeakoulun (Savonia) kanssa. Hankekumppaneina ovat vietnamilaiset Nam Dinh University of Nursing (NDUN) ja Hai Duong Medical Technical University (HMTU), sekä kambodzalaiset International University (IU) ja Bolyno Institute (BNI). Konsortio koostuu hoitotyön, bioanalytiikan ja lääketieteen asiantuntijoista.
Hankkeen tavoitteena on vahvistaa Aasian maiden terveysalan opetusta ja opetussuunnitelmien kehitystyötä HLI-torjunnassa. Se käynnistyi vuoden 2021 alussa ja jatkuu huhtikuuhun 2024 asti. Konsortio on
kokoontunut kuukausittain Zoomin välityksellä. Ensimmäinen lähitapaaminen ja työkokous oli toukokuussa 2022 Coimbrassa Portugalissa. Sen jälkeen työkokouksia on pidetty Nam Dinhissä Vietnamissa, Phnom Penhissä Kambodzassa ja Kuopiossa. Lähitapaamiset ovat olleet tärkeitä luottamuksen ja yhteisen ymmärryksen kasvattajia, sekä mahdollistaneet avoimen keskustelun infektioiden torjunnan päämääristä ja menetelmistä huomioiden kulttuuriset erityispiirteet.
Kulttuuristen erojen ymmärtäminen ja kunnioittaminen on olennainen osa kansainvälisiä projekteja. Hankkeen aikana on huomattu, kuinka tärkeää on tavata ja työskennellä yhdessä. Mitä useammin olemme tavanneet ja tutustuneet kumppanien kesken, sitä tehokkaammaksi tehtävien tekeminen ja tavoitteiden saavuttaminen ovat käyneet. Enenevän verkkotyöskentelyn maailmassa henkilökohtaisten suhteiden arvo onkin ollut virkistävää tässä hankkeessa.
PrevInf-hankkeessa kehitettyjä koulutusratkaisuja PrevInf-hankkeessa on kehitetty opiskelijakeskeinen HLI-oppimisen ja opettamisen malli, jonka tarkoitus on ohjata opettajien ja opiskelijoiden ajattelua ja tiedon käsittelyä. Mallin keskeisiä elementtejä ovat opiskelijan osaaminen, toiminta, aktiivinen oppimisympäristö ja jatkuva oppimisprosessin laadun arviointi. Lisäksi malli
14 Bioanalyytikko 3|2023
Laboratorionäytteenottokärry Nam Dinhin sairaalassa. Verinäytteenottovälineet Nam Dinhin sairaalassa.
antaa kehyksen HLI-torjunnan implementointiin Aasian maiden opetussuunnitelmiin.
Kumppanit ovat tuottaneet infektioiden torjunnan oppimiseen pdf-muotoisen e-kirjan. Kirja koostuu kahdesta osasta. Ensimmäinen opiskelijoille suunnattu osa käsittelee tavanomaisia varotoimia Aasian maiden näkökulmasta. Kirja sisältää myös kertaavia tietotestejä opiskelijoiden oppimisen tueksi. Toinen opettajille suunnattu osa, käsittelee lisäksi simulaatiopedagogiikkaa, skenaariopohjaisen simulaation käsikirjoittamista ja toteuttamista sekä simulaation implementointistrategiaa opetussuunnitelmiin. Molempien osien alussa esitellään PrevInf-hanke ja PrevInf-malli. Kirja julkaistaan internetissä kaikkien vapaaseen käyttöön.
HLI-oppimista ja opettamista on kehitetty simulaatiomenetelmällä. Skenaariopohjainen simulaatio rakentuu orientaatio- ja toimintavaiheista sekä oppimiskeskustelusta. Tutkimusten mukaan skenaariopohjainen simulaatio on tehokas tapa oppia HLI-torjuntaa ja potilaan kokonaisvaltaista hoitoa. Opiskelijat pystyvät autenttisissa tilanteissa soveltamaan muun muassa teknisiä, taidollisia, yhteisöllisiä ja päätöksentekotaitoja. Kumppanimme ovat olleetkin innokkaita kehittämään infektioiden torjunnan koulutusta simulaation keinoin, ja he ovat tuottaneet useita HLI-torjunnan skenaariopohjaista simulaatiokäsikirjoitusta. Hanke on myös mahdollistanut simulaatiovälineistön hankkimisen hankkeessa mukana oleviin oppilaitoksiin.
Lähitapaamiset ovat olleet suuri apu simulaatiomenetelmän ymmärtämiseen. Aasialaiset opettajat ovat päässeet itse harjoittelemaan menetelmää käytännössä. Simulaatioiden jälkeen on käyty analyyttisiä keskusteluja ja rakentavien palautteiden avulla osallistujille on selkeytynyt menetelmän eri vaiheiden tarkoitus.
Paikallisiin olosuhteisiin tutustuminen
Laadukas opetus ja kokonaisvaltainen ymmärrys infektioiden torjunnan keinoista on askel kohti laadukasta potilaan hoitoa. Kuitenkin infektioiden hallinta Aasian hoitoympäristöissä voi olla haastavaa, kuten Nam Dinhin paikallisessa sairaalassa Vietnamissa saimme havaita. Potilaat olivat suurissa huoneissa ja omaiset vastasivat heidän perushoidosta, mikä voi lisätä mikrobien kulkeutumisen riskiä. Käsienpesualtaiden ja käsidesinfektioaineiden puute loi omat pulmansa hygieniakäytänteissä. Jätteiden lajittelu tuli esille laboratorionäytekärryissä, joissa oli astiat särmäis-, biologiselle- ja sekajätteelle. Kärryissä oli myös käsidesinfektiopulloja,
joten käsiä desinfioitiin potilaiden välillä verinäytteenotossa. Suojakäsineitäkin oli saatavilla, mutta niiden käyttö oli vähäisempää.
Tässä sairaalassa verinäytteet otettiin neula-ruiskuyhdistelmällä. Näytteitä ottivat sekä laboratoriohoitajat että sairaanhoitajat. Putkivalikoima vaikutti tutulta, mutta värikoodaus oli erilainen. Meille kerrottiin, että tiloissa, välineissä ja laitteissa on sairaaloiden välillä suuriakin eroja. Esimerkiksi yksityisillä klinikoilla verinäytteenotossa oli käytössä vakuuminäytteenottosysteemi ja turvaneulat.
PrevInf-hankkeessa tuotettujen koulutusratkaisujen levittäminen
PrevInf-hanke lähestyy loppuvaihettaan ja keskittyy kansainvälisten julkaisujen viimeistelyyn. Kaksi julkaisua liittyy HLI-torjunnan oppimiseen ja opettamiseen opiskelijoiden, opettajien ja hoitohenkilökunnan näkökulmista. Toiset kaksi julkaisua raportoi hoitotyön opiskelijoiden ja opettajien kokemuksia skenaariopohjaisen simulaation käytöstä HLI-torjunnan oppimisessa ja opettamisessa.
Syksyllä kumppanit järjestävät myös paikallisesti erilaisia tapahtumia, joissa esitellään PrevInf-mallia, e-kirjaa ja simulaatioita aasialaisille terveysalan toimijoille. Kumppaneilla on mahdollisuus olla edelläkävijöitä HLItorjunnan opettamisessa ja simulaatiomenetelmän käyttöönotossa muissakin Aasin maissa kuin Vietnamissa ja Kambodzassa. Hankkeen sivuihin voi tutustua osoitteessa https://previnf.com/.
Ulla Korhonen, TtM, bioanalytiikan lehtori, Savonia-ammattikorkeakoulu
Leena Koponen, tohtorikoulutettava, TtM, hoitotyön lehtori, Savonia-ammattikorkeakoulu Mikko Myllymäki, TtM, kehittämispäällikkö, Savonia-ammattikorkeakoulu
Marja Silén-Lipponen, FT, yliopettaja, Savonia-ammattikorkeakoulu
Kaipaatko lähdeviitteitä? Laita meiliä toimisto@bioanalyytikkoliitto.fi.
Bioanalyytikko 3|2023 15
PARIOHJAUS OPISKELIJOIDEN

OHJAUSMENETELMÄNÄ
KLIINISESSÄ LABORATORIOSSA
TEKSTI Marja Liehu KUVAT Sahra Mohamed ja Marja Liehu
Sahra suosittelee pariohjausta kliinisen laboratoriotyön harjoitteluun.
Metropolia amk:n bioanalyytikko-opiskelijat Sahra Mohamed ja Farah Duale olivat 10 viikon kemian ja hematologian harjoittelujaksolla Malmin sairaalan laboratoriossa Helsingissä 20.3.–21.5.2023. Harjoittelu toteutettiin pariohjauksena. HUSin laboratoriossa pariohjausta ei ole ennen kokeiltu, joten Sahra ja Farah saivat kunnian toimia opiskelijoina pilottijaksolla. Harjoittelu onnistui paremmin kuin uskalsin odottaa. Opiskelijoita kehuttiin oma-aloitteisiksi, motivoituneiksi, rohkeiksi ja taitaviksi, mikä sinällänsä oli hyvä edellytys pilotin onnistumiselle.
Pariohjaus menetelmänä
Pariohjaus, vertaisoppiminen, peer learning, on opiskelijoiden omaa aktiivisuutta korostava ohjausmenetelmä, joka perustuu vertaisoppimiseen. Siinä kaksi opiskelijaa toimii harjoittelun aikana parina ja heitä ohjaa vuorossa yksi harjoittelun ohjaaja. Pariohjauksessa opiskelijat ratkovat yhdessä harjoittelun aikana eteen tulevia haasteita. Opiskelijat toimivat harjoittelunsa aikana sekä opettajan että oppijan roolissa. Opiskelijoiden tulee aloittaa harjoittelu samaan aikaan ja molemmilla harjoittelujakson tulee olla yhtä pitkä.
Pariohjauksessa ohjaaja antaa opiskelijoille enemmän tilaa oppia toisiltaan verrattuna perinteiseen ohjausmenetelmään, jossa yhtä opiskelijaa ohjaa yksi ohjaaja. Ohjaajan roolissa pariohjauksessa korostuvat havainnoijan ja reflektoijan roolit, lisäksi hän antaa opiskelijoille tilaa ja vastuuta asteittain opiskelijoiden osaamisen mukaan.
Vertaisoppiminen ei ole uusi käsite. Hoitotyön harjoittelussa tapahtuvasta pariohjauksesta löytyy useita artikkeleita. Myös HUSissa on käytössä erilaisia ohjausmalleja. Moduuli- ja pariohjausta on toteutettu jo vuosia hoitotyön puolella. Moduuliohjauksessa ohjaus tapahtuu 3–6 opiskelijan ryhmässä.
Hain tutkittua tietoa pariohjauksesta harjoittelusta kliinisessä laboratoriossa mm. hakusanoilla peer learning, peer to peer, collaborative learning, training, student, biomedical laboratory scientists, medical laboratory technologists, medical laboratory technicians. Löysin postereita sekä opinnäytetyön, joissa käsiteltiin vertaisoppimista laboratoriotyössä. Lisäksi löytyi tietoa vertaistuen vaikutuksesta heikommin menestyvien opiskelijoiden ohjauksessa.
Kliinisessä laboratoriossa tapahtuvaa pariohjausta on pilotoitu Karoliinisessa Instituutissa Ruotsissa, josta
Camilla Linder ja Jenny Flygare kertoivat Kööpenhaminassa pidetyssä IFBLS-kongressissa (International Federation of Biomedical Laboratory Scientists) vuonna 2021. Esityksensä lopuksi he suosittelivat lämpimästi tämän ohjausmenetelmän käyttöönottoa kliiniseen laboratorioharjoitteluun.
Pariohjauksen toteutus
Tästä rohkaistuneena päätin HUSissa Diagnostiikkakeskuksessa testata sitä, miten pariohjaus sopisi suomalaiseen laboratorioon harjoittelumuodoksi. Pilotti toteutettiin keväällä 2023 Malmin sairaalan laboratoriossa opiskelijoiden 10 viikon kemian ja hematologian jaksolla.
Malmin sairaalassa on terveyskeskuspäivystys, pientraumapäivystys, päivystysosasto, valvontayksikkö ja päivystystä tukevat vuodeosastot. Sairaala palvelee ympäri vuorokauden. Harjoittelujaksolla opiskelijat perehtyivät verenkuviin, kemian analysaattoriin, hyytymisanalytiikkaan, eritelaboratorioon, verikaasuihin ja lajittelupisteeseen. Lisäksi opiskelijoita ohjattiin type and screen -verikeskustoimintaan – varsinaista verikeskusta Malmilla ei ole, vaan tarvittavat ristikokeet tehdään Meilahden verikeskuksessa. Harjoitteluun kuului tietenkin myös joka aamuinen aamukierto osastoilla.
Bioanalyytikko 3|2023 17
Pariohjauksessa eli vertaisoppimisessa korostuu opiskelijoiden oma aktiivisuus.
Aiemmin Malmin sairaalan laboratoriossa on ollut kaksi opiskelijaa kerrallaan samaan aikaan harjoittelujaksolla, mutta he ovat olleet yksilöohjauksessa eri työpisteissä. Pilottijaksolla opiskelijoita oli nyt yhtä aikaa kaksi, ja molemmat olivat samaan aikaan samassa työpisteessä.
Ennen harjoittelua pidin Malmin työntekijöille ja Metropolian opettajalle infoja siitä, mitä pariohjaus tarkoittaa, mitä se vaatii opettajalta, ohjaajalta ja miten opiskelijat tulee ottaa huomioon ohjauksen aikana. Infoja tuli pidettyä monta, koska pilotti oli tarkoitus toteuttaa jo syyslukukaudella 2022, mutta tuolloin toisen opiskelijan harjoittelujakson peruunnuttua harjoittelu toteutui tuolloin yksilöohjauksena ja pariohjauspilotointi siirtyi keväälle 2023. Myös keväällä infosin malmilaisia useita kertoja. Lisäksi lähetin materiaalin Malmille tutustuttavaksi. Opiskelijoille pidin oman infon, jossa ohjeistin heitä pariohjaukseen.
Harjoittelun puolessa välissä ja lopussa toteutin omat Forms-kyselyt opiskelijoille ja ohjaajille. Kyselyssä kartoitin miten ne asiat, joista tutkittuun tietoon perustuen pariohjauksessa hyötyy eniten, ovat toteutuneet Malmin harjoittelussa. Harjoittelujakson viimeisellä viikolla kävin haastattelemassa Malmin henkilökuntaa sekä opiskelijoita siitä, miten he ovat kokeneet harjoittelun.
Opiskelijoiden kokemukset pariohjauksesta
Opiskelija Sahra Mohamed kertoo, että harjoittelun ensimmäisellä puoliskolla ohjaajien oli vaikea irtautua opettajan roolista, mutta loppujaksolla on ollut selvästi vapaampaa ja opiskelijat ovat päässeet itsenäisesti tekemään työtä. Opiskelijat ovat saaneet pohtia asioita yhdessä ja lopuksi he ovat pyytäneet paikalle ohjaajan, jonka vastuulla he ovat saaneet jatkaa työtä.
Opiskelijat päättivät heti aluksi, kuinka työt jaetaan. Toinen saa työskennellä itsenäisesti, eikä opiskelijapari puutu siihen. Sitten tehtäviä vaihdetaan keskenään. ”Reflektio meidän opiskelijoiden välillä on ollut päivittäistä ja olemme keskustelleet, jopa kun tilanne on ollut päällä. Ohjaajien kanssa olemme reflektoineet viikoittain”, Sahra kertoo.
Opettavaisen kokemuksen Sahra sai päivästä, jolloin toisen kemian analysaattorin aamukontrollit eivät menneet läpi. Vakiointi jouduttiin tekemään uudelleen, sen jälkeen vaihdettiin uudet vakiot, vakioita ajettiin näytteenä, kontrollit vaihdettiin, kemisti kutsuttiin paikalle. Lopuksi Sahran ehdotuksesta vaihdettiin myös reagens-
sit, jolloin tulokset lopulta näyttivät hyviltä. Tähän kuluikin sitten koko työpäivä.
Erityiskiitokset Sahra antaakin kemistille, joka on osannut selkeästi kertoa myös opiskelijoille analysaattoreiden periaatteista: ”Tästä on ollut todella paljon apua periaatteiden ymmärtämisessä sekä teorian soveltamisesta käytäntöön. Kerran hän jopa piti meille ”pistarit” kysyen, mitä teidän mielestänne tässä on tapahtumassa jne.” kertoo Sahra.
Eri ohjaajilla on ollut oma tapansa tehdä työtä, mikä hämmensi aluksi. Lopulta siitä on kuitenkin ollut myös apua, koska esimerkiksi hematologiassa yksi ohjaaja on osannut kertoa, kuinka trombosyytit katsotaan käyrästä, toinen on osannut selittää pilven merkitystä leukosyyttien jakaumassa, kolmas kertoo, miten numeroita tulee tulkita, joten ohjaajilta on saanut lopulta monipuolista oppia.
”Eräs mieleenpainuva kokemus harjoittelujaksolla oli se, kun otin potilaalta PVK-näytteen. Näytteen leukosyytit olivat yli 40 ja osasimme odottaa, että kohta samalta potilaalta pyydetään myös diffi, ja näin tapah-

18 Bioanalyytikko 3|2023
Farahilla on pelkästään hyvää sanottavaa pariohjauksesta.
tuikin. Vedimme myös itsellemme lasit ja värjäsimme ne. Lasilla oli valtavan paljon blasteja, jotka tunnistimme helposti. Seurasimme myös potilaan tilaa jatkossa ja selvisi, että lääkäri oli diagnosoinut tilanteen leukemiaksi, niin kuin mekin olimme päätelleet. Potilaan tilan nopea huononeminen myös oli järkyttävää. Kun otin hänestä ensimmäisen verinäytteen, hän oli aivan terveen oloinen. Seuraavalla viikolla hän oli jo tosi huonossa kunnossa”, Sahra kuvailee.
Harjoittelun lopulla opiskelijat ovat saaneet tehdä ilta- ja yövuoroja. Vuoroissa ei ole pystynyt olemaan kuin yksi opiskelija kerrallaan, joten parityöskentely ei parina viimeisenä viikkona ole ollut niin tiivistä.
Miten Sahran mielestä harjoittelu toteutuisi, jos opiskelijoita olisi kaksi paria yhtä aikaa? ”Nytkin aamukierrolla on alemman kurssin kaksi opiskelijaa näytteenottoharjoittelussa, ja kaikki vaativat yhden ohjaajan mukaansa, joten jos opiskelijoita on paljon, se vaatii myös paljon ohjaajia ja ohjaajilta.”
Koetko jääneesi jostain paitsi, koska olet työskennellyt parin kanssa? ”En ehdottomasti. Koska olemme olleet kaksi viikkoa yhdessä työpisteessä, niin työtä on saatu tehdä myös itsenäisesti”, sanoo Sahra.
Opiskelija Farah Duale kertoi, että häntä jännitti aluksi tosi paljon, että mitähän harjoittelusta mahtaa tulla. Nyt kun on menossa harjoittelun viimeinen viikko, hänellä on harjoittelusta ainoastaan hyvää sanottavaa ja hän on saanut harjoittelun aikana paljon positiivisia kokemuksia.
Parasta Farahin mielestä harjoittelussa on ollut se, että ei ole tarvinnut tehdä yksin asioita. Hän on myös uskaltanut tehdä asioita enemmän, kun on voinut kysyä parilta, eikä aina ole tarvinnut turvautua ohjaajaan. ”Minulla on ollut tunne, että voidaan pärjätä kahdestaan. Ohjaajan kanssa en ehkä olisi tohtinut tehdä niin paljon asioita itsenäisesti”, Farah kertoo. ”Olen saanut lisää itseluottamusta, kun toinen on ollut vieressä ja olen uskaltanut tehdä asioita itsenäisesti.”
”Reflektoimme koko ajan tekemisiämme, kun seuraamme toisen tekemistä. Ja kun toinen seuraa minua, voin kysyä, mitä mieltä sinä olet”, Farah sanoo ja jatkaa: ”En ole kokenut taakkana, että meitä ohjattavia on ollut kaksi. Päinvastoin – virheet ovat vähentyneet, kun toinen seuraa työn tekemistä ja voi saman tien huomauttaa, jos jokin asia on unohtunut tai menossa väärin, ja näin me molemmat olemme oppineet.”
Kolmivuorotyötä tekevässä laboratoriossa ohjaajat vaihtuvat lähes päivittäin. Toiset ohjaajat ovat haasta-
neet opiskelijoita enemmän ja he ovat kyselleet enemmän. Sen Farah kokee auttaneen paljon harjoittelussa. Laboratorion pienet tilat ovat hankaloittaneet parityöskentelyä. Esimerkiksi eritelaboratorio on niin ahdas, että siellä ei ole mahtunut opastamaan kahta opiskelijaa samalle laitteelle. Senpä takia eritelaboratoriossa ohjaajien piti opastaa opiskelija kerrallaan laitteille.
”Suosittelen ehdottomasti pariohjausta. Parilta voi oppia miksi hän tekee asioita eri tavalla. On tärkeää, että pari on vieressä ja toimii samalla ohjaajana”, toteaa Farah.
Ohjaajia haastatellessa selviää,
pariohjaus on ollut toimiva ratkaisu. Opiskelijat ovat olleet itsenäisempiä kuin yksilöohjauksessa.
Työntekijöiden kokemuksia pariohjauksesta Kemisti Leena Tervo on iloinen kuullessaan ”erityismaininnasta” ja siitä, että pilotti onnistui näin hyvin. Vaikka varsinainen opiskelijoiden opettaminen ja ohjaaminen kuuluukin laboratoriohoitajille, Leenalla on tapana jutustella opiskelijoiden kanssa. ”Jos koen, että he ovat oikeasti kiinnostuneita laitteiden toimintaperiaatteista, laadunhallinnasta tms., innostun monesti selittämään tavallista syvällisemmin. Nämä opiskelijat olivat aidosti kiinnostuneita ja kyselivät itsekin paljon, jolloin oli mukava heitä opastaa. Saan itsekin opiskelijoilta uusia näkemyksiä ja ajatuksia. Pidän perehdyttämisestä”, Leena kertoo.
Osastonhoitaja Amy Leppäsen mielestä suhtautuminen opiskelijoihin on ollut aiempaa avoimempaa. ”Usein tuolla kävellessäni jopa unohdan, että Sahra ja Farah ovat opiskelijoita. Tuntuu, että täällä on ollut paljon rennompaa kuin aiemmin. Tämä voi johtua myös siitä, että opiskelijat ovat olleet olleet motivoituneita ja osaavia.”
Amyn mielestä pariohjaus on hyvä myös jatkossa. Laboratorion pienen koon vuoksi yksi pari olisi jatkossakin paras vaihtoehto laadukkaan ohjauksen varmistamiseksi".
Bioanalyytikko 3|2023 19
että
Ohjaajat ovat voineet raportoida toisilleen opiskelijoiden edistymisestä viestitaulun avulla. Viestitauluun on tehty salasanalla suojattu Excel-taulukko, johon kukin ohjaaja on voinut kirjoittaa opiskelijoiden päivän kulusta. Tässä hankaluudeksi osoittautui se, että ohjaajat eivät aina tienneet taulukosta tai taulukon salasana on ollut hukassa.
Ohjaajia haastatellessa selviää, että pariohjaus on ollut toimiva ratkaisu. Eroja yksilöohjaukseen on esimerkiksi se, että pari jää itsenäisesti miettimään ja tekemään. Tekeminen on tietenkin ohjaajan vastuulla, mutta opiskelijoihin on voinut luottaa enemmän. Opiskelijat eivät ole olleet niin yksin kuin yksilöohjauksessa. Ohjaajat eivät myöskään ole kokeneet taakkana sitä, että ohjattavia on ollut kaksi. Huonona puolena heidän mielestään ollut se, että tilat, mobiilit, kiertokärryt ja ohjaajat loppuvat kesken varsinkin, kun aamukierrolla on ollut lisäksi muita opiskelijoita.
Ohjaajat kokivat, että infot, jotka pidin ennen harjoittelun alkua, selvensivät ohjausta, vaikkakin pieni epäluulo jäi siitä, miten tässä onnistuttaisiin. Epäluulot kuitenkin hälventyivät, kun opiskelijapari sopeutui niin helposti ja ohjaus osoittautui toimivaksi. Pari selvästi jakoi tehtävät itse keskenään: tee sinä tänään tämä, niin minä teen huomenna. Keskeistä harjoittelussa oli parin keskinäinen keskustelu ja vertaistuki.
Vaikeuksia saattaisi tuottaa se, jos pari olisi kovin epäsuhtainen. Tällä kertaa opiskelijat olivat samalla tasolla ja molemmat olivat hyvin oma-aloitteisia.
”Voimme suositella pariohjausta kliinisen kemian laboratorioon!”






Pariohjauksessa opiskelijaparille nimetään kaksi ohjaajaa, jotka ovat päävastuussa ohjauksesta. Malmilla toinen heistä on Riina Vainionpää. ”Pyrimme siihen, että vastuuhoitaja olisi ollut aluksi kolme päivää aluksi sa-

20 Bioanalyytikko 3|2023
PARIOHJAUKSEN HYÖTYJÄ
Opiskelijan vastuuntunto lisääntyy.
Opiskelijan itseluottamus kasvaa.
Opiskelija on valmiimpi työelämään.
Teoria ja käytäntö yhdistyvät.
Opiskelija osaa antaa palautetta paremmin.
01 02 03 04 05 06
Opiskelijapari tuo turvallisuutta työhön.
Kaavio 1. Pariohjauksen hyötyjä.
massa työpisteessä opiskelijan kanssa, mutta tämä ei toteutunut vuorotyön ja äkillisten poissaolojen vuoksi”, Riina kertoo ja jatkaa: ”Nämä opiskelijat olivat todella hyviä ja tekivät rohkeasti kaikkea. En tiedä miten pariohjaus sopii, jos opiskelijat olisivat aivan eri tasoisia”.
Kysyttäessä, mitä eroa ohjaamisessa oli verrattuna yksilöohjaukseen, Riina kertoo, että ohjaajat pyrkivät kaikessa siihen, että opiskelijat tekisivät yhdessä asioita. Hän mainitsee myös ahtaiden tilojen hankaloittamasta ohjauksesta. Eritelaboratoriossa ohjaus oli käytännössä yksilöohjausta.
Voisiko harjoittelussa Malmilla olla jatkossa kaksi paria pariohjauksessa? ”Iltapäivällä voisi ehkä olla, mutta koska aamuisin on ruuhkaa ja näytteenoton harjoittelujaksolla voi olla yhtä aikaa muitakin opiskelijoita, niin ohjaajat loppuvat kesken”, toteaa Riina.
Pariohjausta hän suosittelee lämpimästi sellaiseen laboratorioon, jossa tilat ovat fyysisesti riittävän suuret. Opiskelijoiden täytyy myös olla riittävän itseohjautuvia ja samantasoisia.
Mitä pilotista havaittiin Forms-kyselyn opiskelijoiden vastauksista korostui selvästi itseluottamuksen ja työskentelyvarmuuden kasvu harjoittelujakson aikana. Samoin tiedot ja taidot lisääntyivät paljon harjoittelussa. Lisäksi opiskelijapari toi selvästi turvallisuutta harjoitteluun. Opiskelijoiden numeerinen arvio harjoittelun toteutumisesta olikin täysi kymppi! Ohjaajien arviointeja tuli vain muutamalta (n=3 ja n=4) ja arvioinneissa oli vaihtelua laidasta laitaan. Ohjaajilla hankaluutta vastaamiseen toi se, että monet olivat olleet opiskelijoiden kanssa vain päivän tai korkeintaan pari, jolloin harjoittelun kokonaisuutta on luonnollisesti vaikea arvioida.
Pariohjauspilotista useissa puheenvuoroissa esille tulleita asioita:
• Ohjaajien huoli siitä, jos opiskelijapari ei ole tasavahva. Pelko siitä, että toinen opiskelija jäisi toisen varjoon.
• Oppilaitoksen iso vastuu; myös opettajien tulee sitoutua pariohjaukseen sekä heidän tulee osata valita ohjaukseen sopivat opiskelijat.
• Jos laboratorion tilat ovat ahtaat, ei opiskelijoita mahdu enempää, vaikka tahtoa olisi.
• Alkuperehdytys ja harjoittelun suunnittelu korostuu.
• Vaihtuvien ohjaajien keskinäinen kommunikointi ja opiskelijoiden edistymisen kirjaus tulee olla selkeää.
• Viikoittainen palautteen anto ja reflektiohetki on hyvä kirjata kalenteriin, jotta se toteutuisi.
Lopuksi
Itse hämmästyin siitä, että kaikki mitä olin lukenut pariohjauksen hyödyistä, tuli niin selvästi esille haastatteluissa sekä Forms-kyselyissä. Kaikki tämä kuulosti niin upealta, että kuunnellessani opiskelijoita ja ohjaajia ihmettelin, miksei tällaista harjoittelumuotoa ole aiemmin toteutettu. Toki haastatteluissa ja palautteissa tuli useasti esille, että pilottijaksolla oli motivoituneet ja näppärät opiskelijat, mikä oli onnistuneen pariohjauksen edellytys.
Kaiken tämän jälkeen voin vain suositella pariohjausta myös kliiniseen laboratorioon. Kuinka me olemme tulleet ennen toimeen ilman pariohjausta!
Marja Liehu, kliininen opettaja, laboratoriohoitaja, TtM, Metropolia-amk
Kaipaatko lähdeviitteitä? Laita meiliä toimisto@bioanalyytikkoliitto.fi.
Bioanalyytikko 3|2023 21
Laboratoriolääketiede ja näyttely Marina Congress Center
5.–6.10.2023
Päihderiippuvuus kroonisena aivosairautena
Miksi virheelliset terveysuskomukset pysyvät, vaikka tutkittu tieto lisääntyy?


22 Bioanalyytikko 3|2023 YHTEISLUENNOT
Virolainen
Atte
Somepäihdelääkäri A-klinikkasäätiö
Juhani Knuuti Professori Turun yliopisto
PERJANTAI 6.10. klo 8.30 TORSTAI 5.10. klo 9.00
lablt.fi
TOMATO-SHOW
TORSTAI 5.10. klo 17.00-17.45
Iloitaan, innostutaan ja piristytään!

Tom Pöystin ja Mato Valtosen show täynnä huumoria, hurmosta ja huikeita tarinoita!
Tervetuloa seuraamaan show’ta luentojen jälkeen juuri ennen Get-together-tilaisuutta!
VALITSE OMA LUENTOPOLKUSI:
TORSTAI 5.10.
• Sydän- ja verisuonitautien ennustamista ja diagnostiikkaa
• Ympäristöystävällinen laboratorio
• Kliinistä fysiologiaa: sydän ja keuhkot
• Ajankohtaista hematologiaa
• Kovakudosdiagnostiikan monet kasvot
• Vaikuttavaa vieritestausta ja käytännön
kokemuksia
• Näkökulmia kliinisten laboratorioiden
tulevaisuuteen
• Kliinistä fysiologiaa ja neurofysiologiaa
• Potilas keskiössä –taitoja potilaan
kohtaamiseen
PERJANTAI 6.10.
• Potilaan ohjauksen, näytteenoton ja näytteiden käsittelyn parhaat tai uudet toimintatavat
• Päivitä tietosi mikrobiologian alalta
• Koulutus osana bioanalyytikon
ammatillisen osaamisen vahvistamista
• Solujen monet kasvot mikroskoopilla
• Raskaudenaikaiset sikiöseulonnat 2023
• Työhyvinvointi – mitä se on ja mistä sitä saa?
• IVDR-asetus (EU 2017/746) –
Laboratorion oma laitevalmistus –Työpaja
Motivaatio, hyvinvointi ja kokemus työn merkityksellisyydestä tuo sote-alalle osaavia ja työtään arvostavia ammattilaisia myös
tulevaisuudessa
Työhyvinvoinnin kehittäminen on noussut maailmanlaajuisesti yhdeksi tärkeimmistä työelämän puheenaiheista, sillä työhyvinvoinnin tiedetään olevan keskeinen tekijä hyvin menestyvien yksilöiden ja organisaatioiden taustalla. Työhyvinvoinnin ylläpitäminen edellyttää kuitenkin pitkäjänteistä ja henkilöstöä arvostavaa johtamista, jossa huomioidaan sekä työelämän että yksilön inhimilliset tarpeet ja odotukset. Globaalit epävarmuustekijät ovat nostaneet entuudestaankin tutun osaajapulan esiin sote-alalla työtapojen muuttuessa sekä maailmanlaajuisen irtisanoutumis- ja alanvaihtoilmiön kiihtyessä.
24 Bioanalyytikko 3|2023
TEKSTI Mari Moberg & Tuuli Lahti KUVAT Adobe Stock
Viimeaikaisista terveysalan tutkimuksista välittyykin tarve työhyvinvoinnin kehittämiselle organisaatioissa toimintakyvyn säilyttämiseksi. Johtamisella on merkittävä vaikutus sote-alan ammattilaisten työhyvinvointiin ja heidän päätökseensä jäädä tulevaisuudessakin alalle. Tässä artikkelissa tuodaan esiin työhyvinvoinnin, sisäisen motivaation ja työn merkityksellisyyden johtamisen vaikutuksia työhön sitoutumiseen ja alan houkuttavuuteen.
Merkityksellinen työ on yksilöllinen kokemus
Työn merkityksellisyyden kokemus on hyvin yksilöllinen. Osa sote-alan ammattilaisista, suuresta työmäärästä ja potilaiden sekä viranomaisten kasvavista vaatimuksista huolimatta, raportoi korkeaa työtyytyväisyyttä ja positiivista asennetta työhönsä, mikä selittyy erityisesti työn merkityksellisyydellä. Osa ammattilaisista tuntee merkityksellisyyttä työssään voidessaan vaikuttaa myönteisesti asiakkaan elämään, esimerkiksi häntä tukien ja hänen vointiaan edistäen.
Organisaation ja ammattilaisten yhteiset arvot ja aika lisäävät työn merkityksellisyyden kokemusta sekä luottamuksen ja ilon tunteita työpaikalla. Esimerkiksi yhdessäolo, yhtenäinen palautekulttuuri sekä säännöllinen vuorovaikutus, jossa korostuu aito välittäminen ja vastuun kantaminen, vahvistavat kokemusta merkityksellisyydestä. Myös ammattiylpeys on suuri voimavara, joka lisää myös työn merkityksellisyyden tunnetta, kunhan työn muutkin osa-alueet ovat kunnossa.
Hyvinvointi työssä ja sote-alan houkuttavuus
Yhteisöllisyyden merkitys työhyvinvoinnin edistämisessä on kasvanut koronapandemian jälkeisessä työelämässä. Hyvinvoivassa organisaatiossa henkilökunta tuntee olevansa arvostettu esihenkilöidensä, kollegoidensa ja potilaidensa silmissä. Tätä tunnetta vahvistavat myös kilpailukykyinen palkkaus (palkkiot), hyvät työajat (joustavuus), edut ja selkeä vastuunjako (tehtäväkuvaukset). Myös työn saavutukset ovat tärkeitä ja hyvin suoritettu työ koetaankin palkitsevana.
Autonomialla on myös suuri merkitys työhyvinvoinnin kannalta, sillä erityisesti ammattilaisen vapaus tehdä organisaatiossa asioita hänelle osoitetun tehtävän sisällä ja mahdollisuus hallita ajankäyttöään koetaan tärkeiksi. Auditoinnit ja määräykset sekä muu ulkoa päin tuleva yllättävä paine voivat aiheuttaa ammattilaiselle tunteen autonomian menettämisestä ja tämän välttämiseksi olisi aina tärkeää ottaa ammattilaiset mukaan
kehitettäessä käytäntöjä ja suunniteltaessa organisatorisia muutoksia.
Johtajuuden merkitys työhyvinvoinnin edistämisessä liittyy erityisesti organisaation kehittämiseen, hyvinvoinnin tukemiseen ja työn merkityksellisyyden kokemuksien vahvistamiseen. Tämän lisäksi työhyvinvoinnin edistäminen organisaatiossa vaatii jokaisen ammattilaisen omien asenteiden ja ajattelutapojen tarkastelua. Vastuu hyvinvoinnista edellyttää organisaatiokulttuurilta avoimuutta ja läpinäkyvyyttä sekä jatkuvaa vuoropuhelua.
Tutkimusten perusteella sote-alan ammattilaiset pitävät houkuttelevina sellaisia organisaatioita, jotka mahdollistavat heidän osallistumisensa päätöksentekoprosesseihin, oman osaamisensa kehittämiseen sekä työn itsenäisyyden lisäämiseen. Sen sijaan liiallinen työmäärä, hallinnollinen taakka, kuormitus, kiire, toimimattomat suoritusten arviointijärjestelmät ja tunnustuksen puute ovat tekijöitä, jotka näyttävät tutkimusten perusteella alentavan sote-alan ammattilaisten työhyvinvointia ja työn houkuttavuutta.
Yksilöllisten tarpeiden huomioiminen sote-alan työhyvinvoinnin johtamisessa
Lähivuosina ammattitaitoisen henkilöstön osalta joudutaan yhä useammin miettimään, miten sote-alan organisaatio tai yksittäinen työyhteisö voivat luoda kulttuurin, joka vetää ammattilaisia puoleensa.
Tutkimusten mukaan keskeisimmin työhyvinvoinnin parantamiseen sote-alalla näyttävät vaikuttavan työkiireen vähentäminen, työroolien ja tavoitteiden selkeyttäminen, motivaation kasvattaminen, yksilöllisyyden huomioiminen, työn arvostus ja vuorovaikutus. Erityisesti epäselvät työroolit heikentävät tutkimusten mukaan työn merkityksellisyyden kokemusta sote-alalla globaalisti.
Bioanalyytikko 3|2023 25
Vastuu hyvinvoinnista edellyttää organisaatiokulttuurilta avoimuutta, läpinäkyvyyttä ja jatkuvaa vuoropuhelua.
Työhyvinvoinnin kehittämiseksi on tärkeää luoda selkeät, työyhteisön yhdessä laatimat henkilö- ja ryhmäkohtaiset tavoitteet toiminnalle ja sitä kautta lisätä työstä innostumista, luovuutta ja motivaatiota työhön. Esihenkilöiden tulee kuunnella ja huomioida kunkin ammattilaisen yksilölliset tarpeet ja odotukset työn ominaisuuksista työstressin ja työuupumuksen sekä ammatinvaihtohalukkuuden vähentämiseksi.
Sote-alan työhyvinvointi ja jopa työllistettävyys tai urapotentiaali voidaan säilyttää, vaikka työtarpeiden määrää on vaikea vähentää, kun laajennetaan ymmärrystä työkestävyydestä ja sen vaikutuksesta työuupumuksen ehkäisyyn ja ammatin vaihtohalukkuuteen.
Yhteisöllisyys ja vuorovaikutus ovat tärkeitä voimavaroja ja työvoimaresursseja. On tärkeää, että esihenkilö ymmärtää selvästi työntekijöidensä odotukset ja edistää heidän työtyytyväisyyttään ja affektiivista sitoutumistaan organisaatioon. Myös työtehtävien vaatimusten ja työresurssien luonteen huomioiminen on tarpeen työn merkityksellisyyden johtamisessa. Näiden tekijöiden vaikutuksesta syntyy turvallinen työilmapiiri, jossa työmotivaatio, vuorovaikutus sekä sitoutuminen organisaatioon lisääntyvät.
Yhteistyöllä iloa työhön
Palkitsemismahdollisuudet, työn luonteen muokkaaminen yksilöllisesti, ohjauksen riittävyys, vuorovaikutus sekä koulutus- ja kehittymismahdollisuudet ovat sote-alan ammattilaisten työhyvinvointiin ratkaisevasti vaikuttavia tekijöitä ja näihin seikkoihin panostamalla myös työn houkuttavuus lisääntyy. Koko organisaation halu kehittyä ja oppia uutta lisää motivaatiota ja työhyvinvointia sekä auttaa kokemaan välillä raskaatkin työt mielekkäämpinä. Työtahdin ja työmäärän yhteensovittaminen vähentää stressiä, turhautumista ja ärsytystä sote-alan organisaatioissa. Sosiaalisen tuen merkitys sekä osallistuminen ongelmien ratkaisuun vähentää työntekijöiden sairauspoissaoloja, stressaavan työympäristön negatiivisia vaikutuksia sekä mahdollista ammatinvaihtohalukkuutta.
Yhteiset perusarvot ja positiivinen asenne organisaatiossa vahvistavat myönteistä ilmapiiriä, mikä lisää myös organisaation tuottavuutta, esimerkiksi asiakaspalvelun parantuessa. Työnilo voi olla läsnä korkeista työkuormista huolimatta ja toimia motivaattorina sekä henkilökohtaisten tyytyväisyyden tunteiden luojana, jos organisaatiolla on myös muita ominaisuuksia, jotka tukevat sisäistä motivaatiota.
Hyvinvoiva sote-alan organisaatio osaa hallita merkittäviä stressin tai trauman lähteitä lieventämällä työn vaatimuksia ja niiden vaikutuksia (työstressi, uupumus, väsymys) sekä sopeutua niiden hallintaan. Yksilön hyvinvointi auttaa työntekijää sopeutumaan positiivisesti työpaikan stressitekijöihin, välttämään psyykkisiä haittoja ja jatkamaan turvallisen ja laadukkaan potilashoidon tarjoamista. Sote-alan ammattilaisten positiiviset kokemukset ja näkemykset organisaatiosta voivat muuttaa työn ominaisuuksien arviointia myönteisemmiksi, vaikka työympäristö säilyisi ennallaan. Luottamus organisaation toimintaan yleisestikin syntyy sen kautta, että tuntee luottavansa oman tiiminsä ja esimiehensä toimintaan.
Yhteenveto
Viime vuosien aikana terveydenhuollon haasteet ovat nousseet entistä voimakkaammin esiin ja huoli terveysalan tulevaisuudesta on vain kasvanut. Organisatorisilla ja ammatillisilla asenteilla on tärkeä rooli myös
26 Bioanalyytikko 3|2023
sote-alan ammattilaisten mahdollisissa aikeissa luopua alan työstä tulevaisuudessa. Kehitys sote-alalla on nopeaa ja jatkuvaa mm. uusien hoitomuotojen kehittymisen ja uusien sairauksien löytymisen myötä, mikä tuo omia haasteitaan myös bioanalyytikoiden työhön.
Akuuttisairaanhoito lisääntyy ja toisaalta pitkäaikaishoidossa on yhä enemmän monisairaita potilaita perusterveydenhuollon yksiköissä, mikä osaltaan vaikuttaa myös näytteenottomäärien kasvuun sekä näytelogistiikan kehittämiseen. Resurssiongelmat sote-alalla ovat lisääntyneet moninaisten muutosten myötä ja lisäävät myös alueellisia haasteita. Uudet lähestymistavat mm. tietohallinnan ja eri alojen lisääntyvän yhteistyön myötä tuovat uutta tietoa sekä ideoita myös hyvinvoinnin kehittämiseen käytännössä ja sitä kautta mahdollistaa sote-alan vetovoiman kasvattamisen.
Yksilöt, jotka ovat tyytyväisempiä työhön ja elämäänsä sekä ovat sitoutuneempia ammattiinsa, hyödyntävät paremmin ongelmakeskeisiä selviytymiskeinoja, kokevat työnsä vähemmän stressaavaksi sekä pitävät uraansa enemmän tärkeänä. Vaikuttaminen ja osallistuminen päätöksentekoon tehostaa kommunikaatiota ja saattaa parantaa sote-alan työntekijöiden työympäristön rakenteellisia kehyksiä. Sote-alan henkilöstöstrategioiden suunnittelussa tällaiset asiat huomioimalla
voidaan mahdollisesti säilyttää nykyiset ammattilaiset alalla ja varmistaa lisääntynyt ja kestävä rekrytointi tulevaisuudessakin.
Mari Moberg, Sosiaali- ja terveysalan kehittäminen ja johtaminen, Tradenomi YAMK, Turun ammattikorkeakoulu
Tuuli Lahti, Yliopettaja, Terveys ja hyvinvointi, Turun ammattikorkeakoulu
Kaipaatko lähdeviitteitä? Laita meiliä toimisto@bioanalyytikkoliitto.fi.
Bioanalyytikko 3|2023 27 #BOOP2024 Valtakunnallinen Bioanalyytikko-opiskelijoiden opintopäivä, #BOOP2024 järjestetään Helsingissä lauantaina 3.2.2024! Suunnittele #BOOP2024-opintopäivään haalarimerkki! Lähetä suunnitelmasi viimeistään 10.11.2023, lisätietoa www.bioanalyytikkoliitto.fi.

TEKSTI Niina Wahlroos KUVA AdobeStock
tekijä tuntee olonsa turvalliseksi, palautetta voidaan antaa avoimesti, ja virheet käsitellä asiallisesti. Tällöin tutkitusti työyhteisö toimii tehokkaammin ja saa parempia tuloksia aikaan.
TURVASSAtöissä
Psykologinen turvallisuus sanapari toistuu monissa eri työhyvinvointia käsittelevissä artikkeleissa, mutta mitä sillä oikeastaan tarkoitetaan? Käsite on ollut olemassa jo pitkään, mutta Amy Edmondsonin johtajuuden tutkimusten myötä se on noussut tämän hetken muotisanaksi.
Psykologisella turvallisuudella tarkoitetaan sitä, että työyhteisön jäsenet tuntevat olonsa turvalliseksi epätäydellisyydestään huolimatta. Työterveyslaitos määrittää psykologisesti turvallisen työyhteisön paikaksi, jossa ”jokainen voi tuoda esiin ideoita ja keskeneräisiä ajatuksia, kysyä kysymyksiä, nostaa esiin huolia, pyytää apua ja myöntää virheitä ilman, että joutuu pelkäämään tulevansa nolatuksi, vähätellyksi tai rangaistuksi”.
Kaikkien työyhteisöjen kohdalla tämä oikeus ei kuitenkaan ole itsestään selvää. Työyhteisön psykologinen turvallisuus saattaa säröillä monesta syystä: virheen tapahtuessa syyllistetään virheentekijää, kehitysehdotuksia ei kuunnella tai apua pyytävään kollegaan suhtaudutaan negatiivisesti.
Maailma ympärillämme muuttuu jatkuvasti: tänään tekemämme työ on hieman erilaista kuin eilen. Työelämässä on jatkuvasti opittava uusia asioita ja mukauduttava. Laboratoriomaailmassa tämä tarkoittaa muun muassa sitä, että käyttöön otetaan uusia menetelmiä, uusia ammattiryhmiä integroituu laboratorion arkeen ja organisatorisia muutoksia tapahtuu. Psykologinen turvallisuus antaa meille mahdollisuuden oppia. Kun työn-
Työyhteisöissä, joissa työntekijät eivät tunne olevansa psykologisesti turvallisessa ympäristössä, seurauksena on ongelmien vaientaminen. Kun ongelmista vaietaan, ongelmat pysyvät työyhteisössä. Se johtaa vähitellen työhyvinvoinnin heikentymiseen, työntekijöiden osallisuushalukkuus vähenee ja samoin sitoutuminen. Psykologisen turvallisuuden puute vaikuttaa siten sekä työyhteisön toimintaan että sen viihtyvyyteen.
Psykologista turvallisuutta voidaan luoda monin tavoin. Esihenkilön toiminnalla ja antamalla roolimallilla on merkittävä asema. Kun hän palkitsee eikä lyttää asioita esille tuovaa henkilöä, se kannustaa työyhteisön jäseniä tuomaan asioita esille jatkossakin. Pikkuhiljaa tapa juurtuu koko työyhteisöön, kun sen jäsenet huomaavat, että epäkohtien tai ongelmien esiintuominen käynnistää työyhteisön oppimisprosessin, ei viestintuojan tuomitsemista.
Työyhteisön jäsenten selkeät roolit ja tavoitteet lisäävät myös psykologista turvallisuutta. Jos ei ole selvää, mitä aiotaan saavuttaa, on myös vaikeampaa puuttua ongelmiin eli tavoitteeseen pääsyn esteisiin.
Psykologisen turvallisuuden keskiössä on oppiminen. Kun työyhteisössä huomataan, että ongelmien esiin nosto tarkoittaa asioiden korjaamista oppimisen kautta, niin silloin kaikki ovet ovat auki hyvinvoivalle, kehitttymiskykyiselle työyhteisölle.
Bioanalyytikko 3|2023 29
Bioanalyytikko-opiskelijoiden näkemys alan veto- ja pitovoimatekijöistä
Sosiaali- ja terveydenhoitoalan haasteiksi tunnistetaan yhteiskunnassa ja sen rakenteissa tapahtuvat muutokset, koulutetun henkilökunnan väheneminen sekä alalta poistuminen.
Tämä vaikuttaa kilpailuun työntekijöistä ja heidän sijoittumiseensa työmarkkinoilla. Bioanalyytikot ovat sosiaali- ja terveydenhoitoalan pienen erikoisalan ammattiryhmä, joiden ammatillinen asiantuntijuus on korvaamatonta kliinisessä laboratoriotyössä. Opiskelujen aikaisella työharjoittelujen
ohjauksella ja työhön perehdytyksellä voidaan lisätä ammatillista vetovoimaa ja pitovoimaa. Alan vetovoimaisuuden lisääminen ja pitovoiman kehittäminen jo opiskeluvaiheessa lisäävät alalla pysymistä ja ammattiin sitoutumista.
30 Bioanalyytikko 3|2023
TEKSTI Tiina Kokkonen, bioanalyytikko AMK, Metropolia Ammattikorkeakoulu & Tiina Virtanen, bioanalyytikko AMK, Metropolia Ammattikorkeakoulu KUVA AdobeStock
Johdanto
Bioanalyytikoita tarvitaan työelämään enemmän, kuin heitä on tarjolla. Kliinisen laboratorioalan suureksi haasteeksi tunnistetaan osaavan henkilökunnan riittävyys. Laboratoriohoitajien lähivuosien eläköitymisen myötä alalle siirtyy uusia kliinisen laboratoriotyön ammattilaisia, jotka tarvitsevat ammatilliseen kehittymiseensä tukea erityisesti työuran alkuvaiheessa.
Työnantajien haasteena on tunnistaa työssä pysymiseen ja sitoutumiseen vaikuttavia tekijöitä. Sukupolvien välillä on eroavaisuuksia siinä, miten työhön suhtaudutaan ja mitä työelämältä halutaan. Työvoimapulaa ei kyetä ratkaisemaan pelkästään koulutuspaikkojen lisäämisellä, vaan tarvitaan alan vetovoimaa ja pitovoimaa lisääviä toimenpiteitä. Työvoiman vähäisyys ja työskentelyolosuhteet heikentävät hoitajien halukkuutta työskennellä alalla, minkä takia mielikuva sosiaali- ja terveydenhoitoalasta on heikentynyt. Tällä on suoraa vaikutusta sosiaali- ja terveysalan vetovoimaisuutta ja pitovoimaisuutta kohtaan.
Artikkeli pohjautuu opinnäytetyöhön, jonka tarkoituksena oli selvittää alalle kouluttautuvien bioanalyytikko-opiskelijoiden kokemaa ammatin veto- ja pitovoimaisuutta sekä kartoittaa työharjoittelujen ja perehdytyksen yhteyttä alan veto- ja pitovoimatekijöihin. Opinnäytetyöhön liittyvä kyselytutkimus toteutettiin sähköisesti keväällä 2023 Metropolian, Savonian ja Oulun ammattikorkeakoulujen bioanalyytikko-opiskelijoille (n = 128). Kyselyn mittausasteikkona käytettiin 5-portaista Likert-asteikkoa (1= täysin eri mieltä ja 5= täysin samaa mieltä). Aineistosta saadut vastaukset analysoitiin tilastollisten menetelmien avulla. Kyselytutkimuksesta saatujen keskeisten tulosten keskiarvot ovat esiteltynä taulukossa 1.
Alan vetovoima ja pitovoima
Korkeakoulutuksen vetovoimaisuuden todetaan heijastelevan sosiaali- ja terveysalan ammattien vetovoimaan. Opinnäytetyön kyselyn tulosten perusteella bioanalyytikko-opiskelijat tunsivat vetovoimaisuutta tulevaa ammattialaansa kohtaan ja opiskelijat olivat ylpeitä tulevasta ammatistaan. Tuleva ammattiala koettiin henkilökohtaisesti tärkeäksi ja opiskelijat kokivat tulevan ammattinsa merkitykselliseksi. Ammattialan valinta tuntui oikealta ja ammatinvaihtajat kokivat tehneensä oikean ratkaisun vaihtaessaan ammattia. Opintojen aikana opiskelijoille oli muodostunut yhteenkuuluvuuden tunnetta bioanalyytikoiden ammattikuntaa kohtaan ja yhteenkuuluvuuden tunne kasvoi vastaajilla opintojen
edetessä. Tulosten perusteella ammatin vahvaksi vetovoimaisuustekijäksi nousi työnkuvan monipuolisuus. Ammatin kehittymis- ja etenemismahdollisuudet koettiin melko hyviksi. Lisäksi opiskelijoiden vastauksista nousi vahvasti esille jatkuvan ammatillisen kehittymisen ja oppimisen halu tulevalla ammatillisella uralla.
Kyselyyn vastanneiden bioanalyytikko-opiskelijoiden vastauksista ilmeni, ettei tulevaa ammattialaa tunnettu eikä arvostettu yhteiskunnassa. Opiskelijoiden itsensä kokema mielikuva ammattialan vetovoimaisuudesta oli vastauksissa neutraali. Sosiaali- ja terveysala on nähty julkisuudessa viime vuosien aikana erityisesti haasteiden ja kriisien valossa. Alan työtehtävissä on kuitenkin paljon vahvuuksia ja työn mielekkyyttä lisääviä tekijöitä, joista tulisi viestiä aktiivisemmin vetovoiman edistämiseksi. Kyselyyn vastanneet opiskelijat olivat innokkaita siirtymään bioanalyytikon ammattitehtäviin heti valmistumisen jälkeen, mutta vastauksissa oli hajontaa siinä, pysyvätkö opiskelijat ammattialalla koko työelämän ajan. Tuloksista ilmeni, että aikaisempi sosiaali- ja terveysalan ammatti ja ikä taustamuuttujina vaikuttivat ammatissa pysymiseen positiivisesti. Koko työuran ajaksi samalle työantajalle sitoutuminen oli kaikkien vastaajien keskuudessa alhaista.
Kyselyssä kartoitettiin bioanalyytikko-opiskelijoiden mielipiteitä ammatin pitovoimaisuuteen vaikuttavista tekijöistä. Tuloksissa tärkeimmiksi ammatissa pysymisen syiksi nousivat työn vaativuutta vastaava palkka, työn merkityksellisyys, riittävät henkilöstöresurssit, mahdollisuus ammattitaidon kehittämiseen ja uralla etenemiseen. (Kuvio 1.)
Kyselyn perusteella osalla bioanalyytikko-opiskelijoista esiintyi opintojen lopettamishaluja kesken koulutuksen. Vastauksissa tärkeimmiksi opintojen keskeyttämisen syiksi nousivat epävarmuudet tulevan ammattivalinnan oikeellisuudesta, kokemus liian vähäisestä tuesta ja ohjauksesta opinnoissa, epävarmuus omista kyvyistä tulevassa ammatissa sekä kokemus opintojen yleisestä raskaudesta. Analyysin perusteella
32 Bioanalyytikko 3|2023
Sukupolvien välillä on eroavaisuuksia siinä, miten työhön suhtaudutaan ja mitä työelämältä halutaan.
Taulukko 1. Kyselyn keskeiset Likert-asteikolliset (1= täysin eri mieltä ja 5= täysin samaa mieltä) väittämät ja saatujen vastausten keskiarvot.
opintojen keskeyttämisen harkinnassa ei löytynyt ikäsidonnaisuutta. Aiemman tutkimuksen mukaan opintojen keskeyttäminen ammattikorkeakoulutuksen aikana sekä alan vaihtaminen heti valmistumisen jälkeen täytyy saada hallintaan, silloin kun yhteiskunnassa tavoitellaan pidempiä työuria.
Työharjoittelun vaikutus alan vetovoimaan Harjoittelujaksot ovat olennaisia ammatillisen identiteetin kasvulle. Hyvin suunniteltu, yksilöllinen harjoittelu vahvistaa ammatillisen identiteetin kasvua ja sitouttaa tulevia ammattilaisia työhön. Opinnäytetyön kyselyyn vastanneiden bioanalyytikko-opiskelijoiden mielestä
Bioanalyytikko 3|2023 33 Väittämä Keskiarvo Olen ylpeä tulevasta bioanalyytikon ammatista. 4,40 Koen bioanalyytikon ammatin merkitykselliseksi. 4,60 Koen kuuluvani bioanalyytikoiden ammattikuntaan. 3,76 Koen että bioanalyytikon ammatti on yhteiskunnassa tunnettu. 1,93 Koen että ammattiani arvostetaan yhteiskunnassa. 2,90 Koen että tuleva ammattini on vetovoimainen. 3,13 Koen kehittymis- ja etenemismahdollisuudet hyviksi tulevassa ammatissani. 3,55 Koen tulevan ammattini työnkuvan monipuoliseksi. 4,46 Haluan kehittyä ja oppia jatkuvasti uutta tulevalla bioanalyytikon uralla. 4,57 Työharjoittelun ansiosta pystyin yhdistämään teoriaopetuksen ja käytännön. 4,48 Työharjoittelut tukevat henkilökohtaista ammatillista kasvua. 4,65 Työharjoitteluni toteutettiin yksilöllisesti työpaikalla. 3,87 Kehittyvää asiantuntijuuttani arvostettiin työharjoittelupaikassa. 3,81 Työharjoittelun ansiosta myönteinen käsitykseni alasta vahvistui. 3,86 Työharjoittelu lisäsi kokemaani ammatin vetovoimaisuutta. 3,63 Työharjoittelun aikana koin, että minut otettiin osaksi työyhteisöä. 4,03 Aion hakeutua työharjoittelupaikkaani töihin. 3,64 Aion hakeutua bioanalyytikon töihin heti valmistuttuani. 4,63 Tulen työskentelemään bioanalyytikon töissä koko työurani ajan. 3,13 Koen perehdytyksen itselleni tärkeäksi asiaksi. 4,91 Koen kattavan perehdytyksen lisäävän työpaikan pitovoimaa. 4,85 Koen yksilöllisen perehdytyksen tärkeäksi työelämään siirryttäessä. 4,79 Koen että kokenut perehdyttäjä on tärkeä ammatillisen kehittymisen kannalta. 4,65 Haluan työyhteisöltä tukea perehdytysprosessissa. 4,53 Koen mentoroinnin tärkeäksi ammatillisen kehittymiseni kannalta. 4,26
työharjoittelu mahdollistaa teoriaopetuksen ja käytännön yhdistämisen, lisäksi työharjoittelut tukevat opiskelijoiden henkilökohtaista ammatillista kasvua. Vastausten perusteella opiskelijat kokivat saaneensa hyvää ohjausta työharjoittelun aikana. Kysymys työharjoittelun yksilöllisestä toteutuksesta työpaikoilla jakoi mielipiteitä. Suurimmalla osalla oli positiivinen kokemus, mutta myös eriäviä mielipiteitä löytyi.
Kyselyn tulokset osoittivat, että opiskelijoiden kokema asiantuntijuus kasvoi työharjoittelun aikana. Lisäksi opiskelijat kokivat, että heidän kehittyvää asiantuntijuuttaan myös arvostettiin työharjoittelupaikassa. Työharjoittelut kasvattivat opiskelijoiden intoa bioanalyytikon opintoihin ja vahvistivat heidän myönteistä käsitystään alasta. Tuloksista ilmeni, että työharjoittelut lisäsivät opiskelijoiden kokemaa ammatin vetovoimaisuutta. Aikaisemmassa tutkimuksessa on todettu, että onnistuneen työharjoittelun ja ammatin vetovoimaisuuden välillä oli voimakas yhteys. Opinnäytetyöhön kyselyn tulosten perusteella opiskelijat kokivat, että heidät otettiin mukaan osaksi työyhteisöä työharjoittelun aikana. Aiemmin tehdyn väitöskirjan perusteella työyhteisöllä on suuri merkitys opiskelijan tukemisessa kohti
ammattilaisen roolia työharjoittelun aikana. Tähän vaikuttavat opiskelijan kokema tasa-arvoisuuden tunne ja kohtelu tulevana työtoverina.
Onnistuneen työharjoittelun todetaan toimivan hyvänä ennakoivana rekrytoinnin välineenä. Työpaikoilla tapahtuva laadukas ohjaus, psyykkisesti ja fyysisesti turvallisen harjoittelun varmistaminen, kehittävä palaute sekä opiskelijoiden näkemysten kuuleminen tukevat työhön ja alalle sitoutumista.
Perehdytyksen vaikutus alan pitovoimaan Perehdyttämisellä on suuri merkitys organisaatiolle. Onnistunut ja laadukas perehdytys luo yritykselle arvokkaan kilpailuedun suhteessa muihin yrityksiin. Laadukas perehdytysprosessi ja onnistunut perehdytys luovat edellytyksiä positiiviseen mielikuvan syntymiseen yrityksestä. Onnistunut perehdytys saa uudessa työntekijässä aikaan positiivisia kokemuksia, jolla on merkitystä henkilöstön vaihtuvuuteen.
Kyselyyn vastanneet opiskelijat kokivat perehdytyksen henkilökohtaisesti tärkeäksi asiaksi, lisäksi kattavan perehdytyksen koettiin lisäävän työpaikkojen pitovoimaisuutta. Vastausten perusteella yksilöllinen pereh-

34 Bioanalyytikko 3|2023
Kuvio 1. Opiskelijoiden kokemat tärkeimmät syyt ammatissa pysymiseksi.
dytys on tärkeää työelämään siirryttäessä, myös työyhteisön tuki ja esihenkilön kanssa käydyt keskustelut nousivat vastauksissa tärkeiksi tekijöiksi perehdytysprosessissa. Pahenevan työvoimapulan vuoksi vastavalmistuneisiin hoitajiin kohdistetaan lisääntynyttä painetta ottamaan kokeneempien hoitajien vastuita pian valmistumisen jälkeen. Työelämään siirtymisvaiheen prosessissa valmistumisen jälkeisen ensimmäisen vuoden aikaiset ammatilliset kokemukset ovat tärkeitä ammatissa pysymisen kannalta.
Kokenut perehdyttäjä ja mentorointi nousivat kyselyn tulosten perusteella tärkeiksi asioiksi ammatillisen kehittymisen kannalta. Aiemman tutkimuksen mukaan mentoroinnilla kyetään tukemaan siirtymävaiheessa olevien työntekijöiden ammatillista kasvua ja kehittymistä. Mentoroinnilla on todettu olevan myönteistä vaikutusta hoitajien alalla pysymiseen, työhön sitoutumiseen sekä vähentävän henkilökunnan vaihtuvuutta työyksikössä.
Mentorointitoiminnan mahdollisuudet nähdään ennen kaikkea hiljaisen kokemustiedon siirtämisessä ja uraansa aloittavan hoitajan voimaantumisessa kohti itsenäistä asiantuntijuutta. Mentorointitoiminnalla on positiivinen vaikutus koko työorganisaation oppimisympäristöön, tämä parantaa työpaikan suosiota vastavalmistuneiden työnhakijoiden keskuudessa. Mentorointiohjelman koettiin antavan kokeneemmille hoitajille uuden uramahdollisuuden työpaikalla, vaikuttaen näin positiivisesti houkuttelevan työpaikan luomiseen.
Tutkimuksen luotettavuuteen vaikuttavat tekijät
Tutkimuksen luotettavuutta arvioitiin kriittisesti koko tutkimusprosessin ajan. Luotettavuutta arvioitiin tarkastelemalla tutkimuksen validiteettia ja reliabiliteettia. Tutkimusaineisto analysoitiin kahden eri tutkijan toimesta, tällä varmistettiin tulosten paikkansapitävyys ja luotettavuus. Tutkimuksesta saadut tulokset olivat samansuuntaisia aiempien tutkimustulosten kanssa.
Aineiston analysointiin liittyi tutkimustulosten tulkintaa heikentäviä tekijöitä. Opinnäytetyön kyselyn vastaajamäärän pienuus voi vaikuttaa tutkimuksen luotettavuuteen, kuitenkin kyselyyn vastanneiden opiskelijoiden joukko vastasi taustamuuttujiltaan bioanalyytikon opiskelijaprofiilia. Bioanalyytikoiden kokemista ammattialan vetovoima- ja pitovoimatekijöistä on vähän tutkimustietoa, joten kyselytutkimus tulisi toteuttaa laajemmassa mittakaavassa.
Johtopäätökset
Opinnäytetyön johtopäätöksinä voidaan todeta, että kyselyyn osallistuneet bioanalyytikko-opiskelijat koki-
vat vetovoimaisuutta tulevaa ammattialaansa kohtaan. Bioanalyytikko-opiskelijat ovat innokkaita siirtymään bioanalyytikon ammattitehtäviin heti valmistumisen jälkeen, mutta vastauksissa oli hajontaa siinä, pysytäänkö alalla koko työelämän ajan. Samaan työantajaan sitoutumista koko työuran ajaksi ei koettu tärkeäksi missään ikäluokassa. Nuoremmat sukupolvet odottavat työnantajiltaan enemmän yksilöllisyyden huomioimista, osaavaa lähijohtamista sekä työ- ja vapaa-ajan tasapainoa. Valmistuneiden bioanalyytikoiden ammatissa pysymistä edistetään työolojen parantamisella sekä vertikaalisten ja horisontaalisten urien tukemisella.
Työelämän ja korkeakoulujen on jatkossa kehitettävä yhteistyössä työelämää ja ammattikuvaa moninaisemmiksi ja houkuttelevammaksi vetovoiman lisäämiseksi. Aktiivisempi viestintä bioanalyytikon ammatista ja ammattialan positiivisista puolista edistää alan vetovoimaa.
Työharjoitteluilla kyetään lisäämään ammattialan vetovoimaisuutta sekä opiskelijoiden kokemaa myönteistä kuvaa ammattialasta. Laadukas ja turvallinen työharjoittelu toimii koulutuksen vetovoimatekijänä. Monipuolinen harjoittelu ja vankka pohja ammatillisen kehittymisen kohdalla ennaltaehkäisee koulutuksen keskeyttämisestä sekä alan vaihtoa valmistumisen jälkeen.
Kattavalla perehdytyksellä pystytään lisäämään työpaikkojen pitovoimaisuutta. Työyhteisön ja esihenkilön tuella on suuri merkitys pitovoimaisuuden edistämisessä. Yksilöllinen perehdytys koetaan erityisen tärkeäksi työelämään siirtymisvaiheessa ja perehdytyksellä on suoraa vaikutusta vastavalmistuneen hoitajan ammatissa pysymiseen. Työelämään siirtymisvaiheen prosessissa valmistumisen jälkeisen ensimmäisen vuoden aikaiset ammatilliset kokemukset ovat tärkeitä ammatissa pysymisen kannalta. Laadukkaalla perehdyttämisellä on myös merkitystä työorganisaatiolle, sillä onnistunut ja laadukas perehdyttäminen luo yritykselle arvokkaan kilpailuedun suhteessa muihin yrityksiin.
Mentoroinnilla on myönteistä vaikutusta hoitajien alalla pysymisessä ja työhön sitoutumisessa. Mentorointia tulisi hyödyntää perehdytyksen välineenä kliinisellä laboratorioalalla. Tämän myötä kokeneelle laboratorioalan työntekijälle tarjoutuu uudenlainen työnkuva, jolla on merkitystä kokeneen työntekijän työnkuvan kehittämisessä. Kliinisellä laboratorioalalla pystytään hyödyntämään bioanalyytikon ammattiosaamista mentorointitoiminnan jalkauttamisessa työelämään.
Bioanalyytikko 3|2023 35
Lähteet pyydettävissä toimisto@bioanalyytikot.fi
Nenäsumutteesta ase tuleviin pandemioihin?
Oululainen bioalan yritys lähti kehittämään koronaa vastaan nenäsumuteaihiota Oulun ammattikorkeakoulun bioanalytiikan laboratoriossa.
Tavoitteena oli rokote, joka olisi nykyisiä rokotteita helpompi käyttää.
 TEKSTI Emilia Leskelä, Simo Rasi, Paula Reponen & Jaana Holappa-Girginkaya KUVA AdobeStock
TEKSTI Emilia Leskelä, Simo Rasi, Paula Reponen & Jaana Holappa-Girginkaya KUVA AdobeStock
Suomessa on tällä hetkellä käytössä lapsille suunnattu nenäsumutemuotoinen influenssarokote, mutta koronalle vastaava rokote on maassamme vasta kehittelyasteella. Maailmalla on käynnissä lukuisia tutkimuksia suun tai nenän kautta annosteltaviin koronarokotteisiin liittyen, ja Kiinassa on otettu ainakin yksi jo käyttöön asti.
Ideana on annostella rokote suoraan sinne, missä sitä tarvitaan ja missä mahdollinen tartuntakin tapahtuisi: suoraan hengitysteihin. Tavoitteena on pysäyttää viruksen eteneminen jo ennen sen pääsyä elimistöön.
Ei täysin uusi vieras
Koronaksi yleisesti kutsuttu SARS-CoV-2 koronaviruksen aiheuttama tauti COVID-19 (tulee sanoista corona, virus, disease) on puhututtanut maailmalla viimeisen kolmen vuoden aikana. Pääosin hengitysteitse tarttuva, moninaisia oireita aiheuttava tauti ei kuitenkaan ole ensimmäinen hengitystieinfektioita aiheuttava koronavirus. Sen edeltäjät SARS (Severe Acute Respiratory Syndrome) ja MERS (Middle East Respiratory Syndrome) ovat antaneet hyvät vertailukohdat tutkittaessa uutta koronavirustyyppiä.
Kruunu, jonka perään ei haikailla Koronaviruksen perimästä on saatu tunnistettua geenit jopa 29 eri proteiinille, joiden tehtävistä osa on yhä pimennossa. Tunnetuin ja tämänhetkisen tutkimustiedon perusteella tärkein näistä on koronaviruksille nimensäkin antanut, viruksen pinnalle kruunumaisia rakenteita muodostava piikkiproteiini eli S-proteiini (spike protein).
Piikkiproteiinit ankkuroituvat hengitysteissä esiintyvään ACE2-reseptoriin. Reseptori lukkiutuu piikkiin kiinni, jonka jälkeen seriiniproteaasi (TMPRSS2) ja furiini auttavat piikkiproteiinia muokkautumaan. Furiini kuuluu proproteiinikonvertaaseihin, joka on ryhmä entsyymejä, jotka katalysoivat muun muassa reseptorien aktivaatiota soluissa. Tämän seurauksena virus pääsee solun sisään aloittamaan uusien virusten tuotannon ja leviämään elimistöön. Tutkimusten mukaan SARSCoV-2 kiinnittyy ACE2-reseptoriin merkittävästi edeltäjäänsä SARS:ia vahvemmin. Tämä voisi omalta osaltaan selittää sen, miksi juuri tämä uudempi virus sai aikaan vakavan pandemian.
ACE2-entsyymi on osa valtimopainetta säätelevää reniini-angiotensiinijärjestelmää (RAS), jossa se toimii vastavaikuttajana verisuonia supistavan tekijän valmistamisesta huolehtivalle ACE-entsyymille. Oletetaan, että ACE2-molekyylit kuluvat viruksen tunkeutuessa isäntäsoluun sen avulla, joka taas johtaa RAS:n epätasapainoon. Epäilläänkin, että tämä olisi osaltaan kytköksissä koronan vakavan tautimuodon oireiston syntyyn.
Koska ACE2-entsyymi on eräänlainen entsyymimaailman monitaituri, (sitä esiintyy peräti 72 eri solutyypissä) myös koronan oireisto on moninainen. Hengitysteiden moninaisten oireiden lisäksi tautiin voi liittyä myös maha-suolikanavan oireilua, kuten ripulia, joka ei ole lainkaan ihme, sillä ACE2-entsyymiä esiintyy runsaiten juuri suolen pintaepiteelisoluissa.
Vankkaa sitoutumista
Oululaisen bioalan yrityksen kanssa tehdyssä opinnäyteyhteistyössä lähdettiin valmistamaan immunogeenia, joka rakentuu biotinyloidusta peptidistä (koronaviruksen piikkiproteiinin osa) ja kantajaproteiinista. Kantajaproteiinina käytettiin streptavidiinia, joka on peräisin Streptomyces avidiini -bakteerista. Streptavidiini-biotiini-kompleksi on hyvin pysyvä laajalla pH- ja lämpötila-alueella.
Koska streptavidiini on ihmiselle vieras proteiini, se on hyvin immunogeeninen rakenne ihmisen elimistölle. Peptidi yksinään on rakenteena niin pieni, ettei se ehkä herättäisi tarpeeksi voimakasta immuunipuolustusvastetta. Projektissa käytetty peptidi on rakennettu niin, että se sisältää SARS-CoV-2:ssa esiintyvän neljän kodonin (12 nukleotidin) mutaation, joka voi auttaa piikkiproteiinin tiukkaa sitoutumista ACE2-reseptoreihin.
Lupaavia tuloksia
Menetelmää testattiin ja saatiin aikaan toivottu konstruktio, josta testattiin sellainen molekyylirakenne, joka olisi mahdollisimman immunogeeninen ja rokotteessa toimiva. Tulosten perusteella aikaansaatua rakennetta olisi mahdollista hyödyntää nopean rokotteen mallina. Jatkokehittelyn tiimoilta onkin jo käyty keskustelua ainakin yhden saksalaisen bioalan yrityksen kanssa koskien menetelmän testausta koe-eläimillä.
Emilia Leskelä, valmistunut Oulun ammattikorkeakoulusta bioanalyytikoksi (AMK)
Simo Rasi, toimitusjohtaja, sairaalakemisti, BioOption
Paula Reponen, lehtori, bioanalytiikka, Oulun ammattikorkeakoulu, Sosiaali- ja terveysalan yksikkö Jaana Holappa-Girginkaya, lehtori, bioanalytiikka, Oulun ammattikorkeakoulu, Sosiaali- ja terveysalan yksikkö
Artikkeli perustuu opinnäytetyöhön:
Leskelä, E. 2022. Nenäsumutemuotoisen rokotteen kehittämisprosessi SARS-CoV-2: ta vastaan – menetelmäsuunnittelu ja testaaminen. https://urn.fi/URN:NBN:fi:amk-2022120726770
Bioanalyytikko 3|2023 37
Suomen Bioanalyytikkoliitto ry Finlands Bioanalytikerförbund rf
Sääntömääräinen liittokokous
19.11.2023 klo 10. Ilmoittautuminen alkaa klo 9. Original Sokos Hotel Lakeus, Torikatu 2, Seinäjoki
Alueyhdistysten on ilmoitettava edustajat ja varaedustajat viimeistään 2.11.2023 hallituksen ilmoittamalla tavalla.
Kokous järjestetään vain kokouspaikalla, ei etäosallistumismahdollisuutta.
Osallistuminen liittokokoukseen (liiton säännöt 11 §):
• Liittokokousedustajien määrä jakautuu siten, että alueyhdistykset, joiden jäsenmäärä on alle 200, saavat kaksi (2) edustajaa, alle 600 jäsentä kolme (3) edustajaa ja yli 600 jäsentä neljä (4) edustajaa.
• Jäsenmäärän tarkasteluajankohta on edellisen kalenterivuoden viimeinen päivä.
• Edustajille jaetaan 1 ääni alkavaa 100 jäsentä kohti. Äänet edustajat voivat jakaa haluamallaan tavalla.
• Kunniajäsenellä on läsnäolo- ja puheoikeus liittokokouksessa, mutta ei äänioikeutta. Liiton hallituksen varsinainen jäsen ei saa toimia minkään jäsenyhdistyksen edustajana liittokokouksessa. Hänellä on kuitenkin kokouksessa läsnäolo- ja puheoikeus.
• Kokouksessa käsitellään liiton sääntöjen 12 § mainitut asiat
• Sääntömuutokset (liiton säännöt ja alueyhdistysten mallisäännöt, vaalijärjestys, ammatinkehittämisapurahasäännöt)
Helsingissä 10.6.2023
Liiton hallitus
Haemme vuoden 2023
bioanalyytikkoopiskelijaa
Hamme jälleen Vuoden bioanalyytikko-opiskelijaa!
Ilmianna hänet, joka on liiton opiskelijajäsen, kunnostautunut opinnoissaan tai opiskelijayhteistyön kehittämisessä tai joka on merkittävällä tavalla edesauttanut ammatin tunnetuksi tekemisessä.
Haku päättyy 30.11.2023.
Voittaja julkistetaan #BOOP2024opintopäivässä 3.2.2024.
Lisätietoa www.bioanalyytikkoliitto.fi.
Anna palautetta lehdestä!
Mikä kosketti, mikä tökki? Anna palautetta lehdestä https://www.lyyti.fi/questions/7ad5891cc1.
Seniorit etsivät retkivastaavaa
Kiinnostaisiko ryhtyä liiton senioreiden retkivastaavaksi?
Ota yhteyttä toimisto@bioanalyytikot.fi tai p. 050 302 6504.
38 Bioanalyytikko 3|2023
EPBS Student Forum 2023
EPBS (European Association of Biomedical Scientists) järjestää Maltalla 10.-11.11.2023
Student Forumin, jonka teema on ”Biomedical Scientists: Leaders in Sustainable Change – From Education to Reality”.
EPBS toivoo okaisesta jäsenmaastaan opiskelijaedustajaa osallistumaan tapahtumaan ja esittämään opinnäytetyötään tai muuta tieteellista projektiaan posterimuodossa.
Kiinnostuitko? Ota yhteyttä ammattikorkeakoulusi opettajaan ja toimisto@bioanalyytikot.fi saadaksesi lisätietoa!
Kiinnostaako yrittäminen?
Nyt olisi mahdollisuus ostaa pieni yksityinen kliininen laboratorio (toiminut noin 70 vuotta).
Ota yhteyttä, jos haluat lisätietoja.
Leena Siloaho
Pieksämäen Laboratorio Ky
p. 040 707 4357
leena@laboratoriopalvelut.fi
TEKSTI Mika Paldanius, Yliopettaja, tiimipäällikkö, Oamk
Työelämän liittyvän digitaalisen oppimis- ja kehittämistoiminnan tutkimustietoa tarvitaan jatkossa yhä enemmän. Tekoälyratkaisut ovat jo tulleet arkipäiväämme. Tarvitsemme uutta tietoa siitä, miten voimme optimaalisesti hyödyntää tekoälyratkaisuja niin osaamisen tukena kuin työn kehittämisessä työpaikoilla.
Työelämän digitaalisen oppimisen ja kehittämisen tutkimuksessa on tärkeää huomioida jo aikaisemmin tehtyä oppimistutkimusta. Työelämän kehittämisen ja oppimisen tilanteisiin liittyy paljon moninaisia ja kompleksisia asioita. Moninäkökulmainen ote antaa ilmiöille laajemman tarkastelukulman kuin yhteen teoriaan sitoutumisen.
Tämänhetkisessä tutkimuskirjallisuudessa ei vielä pystytä vielä vastaamaan, miten meidän pitää lähteä soveltamaan tekoälyä käytännön työhön ja oppimisympäristöihin. Meidän pitää ymmärtää moniulotteisimmin tutkimuksen kautta, miten tekoälyn avulla voimme vahvistaa oman osaamisemme kehittymistä niin yksilöinä kuin työyhteisöissä. Olemme uuden äärellä ja tarvitsemme metodologisesti korkeatasoista tutkimusta, jonka pohjana on aikaisempien oppimisen ja kehittämisen kriteerit.
Vuoden 2022 loppupuolella julkaistu ChatGPT on mullistanut jo opiskelua tänä keväänä ammattikorkeakouluissa. Tekoäly muuttaa työnkuvia ja sillä merkittäviä vaikutuksia tulevaan työelämään. Opetus ja oppiminenkin muuttuu ja kehittyy tekoälyn hyödyntämisen kautta. Tietojen ja taitojen hallintaan tarvitaan edelleen osaavia ja ajattelevia ihmisiä, jotka tekevät vaativia määrittelytöitä.
Monimutkaistunen kokonaisuuksien hahmottaminen ja vuorovaikutustaidot ovat tulevaisuudessa merkittäviä taitoja niin työelämässä kuin opinnoissakin. Tekoälytyökalujen kehittäminen jatkuu ja tulevaisuudessa saamme varmasti todistaa uusia mullistavia löytöjä ja parempia suorituksia. Korkeakoulujen on oltavana valppaana tekoälykehitystyön äärellä ja ottaa huomioon omassa toiminnassaan sen, miten työelämään koulutetaan muutoksiin ja joustaviin toimintatapoihin sitoutuneita ammattilaisia.
Bioanalyytikko 3|2023 39
Tekoälyä koulutuksessa, työelämässä sekä kehittämistoiminnassa
Risteilyohjelma
9.00-9.45 liPPUjeN jaKo satamassa (KatajaNoKKa, helsiNKi)
10.10 siiRtymiNeN laiVaaN
10.30 laiVa lÄhtee
10.40-12.30 teRVetUloa! KoKoUstilassa ohjelmaa ja PieNtÄ syÖtÄVÄÄ
13.00-17.00 talliNNassa VaPaata ohjelmaa, mm. joUlUtoRi
17.00 laiVa lÄhtee
20.15 the joUlUBUFFet
21.30- VaPaa-aiKaa laiValla hyVÄssÄ seURassa
7.00-9.30 aamUPalaBUFFet
9.30 laiVa taKaisiN helsiNGissÄ

ilmoittaUtUmiset
27.9. meNNessÄ:
http://bit.ly/ bioanalyytikotmerella

TEKSTI Emilia Leskelä, Simo Rasi, Paula Reponen & Jaana Holappa-Girginkaya KUVA AdobeStock
TEKSTI Emilia Leskelä, Simo Rasi, Paula Reponen & Jaana Holappa-Girginkaya KUVA AdobeStock
